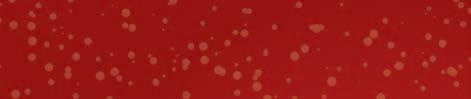

BEL Rioolreinigingsbedrijf B. Langenbach v.o.f. 055-5411660 of 06-55393920 www.langenbachvof.nl








Puzzelen voor prijzen
APELDOORN - We zijn in de laatste maand van 2022 aangekomen en dit betekent onder meer dat het hoog tijd is voor onze Decemberpuzzel. Op liefst acht pagina’s achter in deze krant vindt u de puz zelvakjes van ondernemers in de regio Stedendriehoek. Zij hebben voor deze feestmaand bij uitstek weer een aantal prachtige prijzen beschikbaar gesteld. Wilt u weten welke? Blader dan snel verder, los onze puzzel op en maak kans op een van de fraaie prijzen.
Opbrengst voor hulp













APELDOORN - Op zater dag 10 december van 16.0021.00 uur vindt een gezelli ge kerstmarkt plaats aan de Valkenweg in Apeldoorn. Op deze dag staan een aan tal bewoners met in kerst sfeer versierde kraampjes spullen en eten te verko pen. “De opbrengst willen wij in de vorm van voed sel doneren aan mensen die het goed kunnen gebruiken”, aldus mede-organisator Rein Papenburg. “Nu veel mensen door de oplopende energie rekening en duurdere bood schappen moeite hebben om rond te komen, is het goed om zeker ook in deze feest maand hen op deze manier te ondersteunen.”




Adventsconcert




BEEKBERGEN - Op zater dag 10 december geven de Christelijke Gemengde Zangvereniging Hosanna uit Lieren en het Seniorenorkest De Vriendenkring uit Klarenbeek-Oosterhuizen samen een adventsconcert in de Dorpskerk te Beekbergen. Het concert begint om 19.30 uur, de kerk is open om 19.00 uur. De toegang is vrij, maar bij de uitgang wordt een col lecte gehouden.
Kikker zingt voor de kleintjes
APELDOORN - Kikker, bekend van de boeken van Max Velthuijs, is al ruim der tig jaar favoriet onder kin deren. Regelmatig maakt hij een uitstapje naar het the ater.

Op woensdag 28 december om 14.00 uur is de spiksplin ternieuwe, spetterende fami liemusical Kikker is verliefd! te zien in Theater Orpheus. Een lieve en vrolijke voor stelling voor de allerkleinsten.




Lezers van Nieuwsblad Stedendriehoek maken kans op vrijkaarten.
De voorstelling is gebaseerd op het gelijknamige boek van Max Velthuijs en het betreft
een magisch mooie poppen voorstelling met veel inter actie en humor. Na de voor stelling kunnen theaterbezoe kers Kikker en zijn vriendjes in de foyer van het theater ont moeten en met hen op de
foto gaan tijdens een uitge breide meet & greet. Wie kans wil maken op vrij kaarten, kan tot uiter lijk woensdag 14 decem ber mailen naar: redactie@ stedendriehoek.nl.
Lezing over omgaan met verlies Laatste postzegelbeurs
APELDOORN - Op zaterdag 10 december van 13.30 tot 16.00 uur verzorgt postzegel club BOV de Maten de laat ste postzegel(ruil)beurs van dit jaar in wijkcentrum Op Dreef aan de Kooikersplaats 35 te Apeldoorn. De entree is vrij en er is voldoende par keergelegenheid.




Er is die dag een speciale kerstloterij (met lucifersdoos jes) voor het goede doel: het

Sukabirus schoolproject in Bandung in Indonesië. Het gokje kan lonen, want de organisatie heeft gezorgd voor mooie kerstprijzen.
Jaarafsluiting “Natuurlijk valt er weer veel te snuffelen en te speu ren tussen alle stockboeken en zegels bij onze stand houders. We maken er een gezellige jaarsafsluiting van.”


APELDOORN - Op zaterdag 17 december wordt in de Zwitsalhal aan de Vlijtseweg de lezing ‘Je bent niet alleen’ met Isa Hoes en Merlijn Kamerling georganiseerd. De lezing staat in het teken van hoe om te gaan met het ver lies van een dierbare.

Rouw


































In hun eerste gezamenlij ke boek ‘Je bent niet alleen’ beschrijven moeder Isa Hoes
en zoon Merlijn Kamerling hoe het is om te rouwen om iemand die heel dicht bij je stond. In het geval van Isa en Merlijn was die per soon echtgenoot en vader Antonie Kamerling, maar dit boek is herkenbaar voor iedereen die een broer, zus, kind, ouder of partner verlo ren heeft.
Isa en Merlijn reiken hand vatten aan om met zulk
intens verdriet om te gaan. Ze beschrijven hoe zij hun grote verlies hebben moe ten verwerken. Ze gaan in op de verschillende fases van rouw, hoe je het verdriet niet de overhand laat krij gen, maar ook hoe je leert er niet voor weg te lopen.
Kaarten zijn te bestellen via: tickets.dezwitsalhal.nl/ tickets/isa-hoes-enmerlijn-kamerling



NIEUWSBLAD VOOR APELDOORN-DEVENTER-ZUTPHEN - OPLAGE CA. 154.340 EX. 47e JAARGANG NR. 49 - WOENSDAG 7 DECEMBER 2022 Onbetaalbaar... daarom gratis 68.700 huishoudens .nl
Lees het gemeentenieuws op pagina 7
AFVOER OF RIOLERING?
VERSTOPTE
Koninginnelaan 97 | Apeldoorn | T. 055-5212662 DE GEZONDE ZAAK APELDOORN 10% KORTING op het gehele assortiment van Geldig t/m 17-12-2022 HUIS VERKOPEN? T 055-7601777 GRATIS WAARDEBEPALING Ouderwetse kwaliteit, moderne aanpak! ’’Wij nemen de jd voor u, bij ons bent u geen ’’Wij nemen de jd voor u, bij ons bent u geen nummer! Direct een eerlijke en ne o prijs, geen ’’Wij nemen de jd voor u, bij ons bent u geen nummer! Direct een eerlijke en ne o prijs, geen ’’Wij nemen de jd voor u, bij ons bent u geen nummer! Direct een eerlijke en ne o prijs, geen handjeklap maar alles duidelijk en transparant.’’ GAAN WIJ VERHUIZEN JANUARI 2023 G SLECHTS 2 STRATEN VERDEROP KANAAL NOORD ONS NIEUWE ADRES: LAAN VAN DE DIERENRIEM 38 IN APELDOORN WWW.PIJNAPPEL.NL Jutlandsestraat 3, Zutphen Tel: 0575-517999 - www.kachelswk.nl
uit de gemeente Apeldoorn Nieuws
WELKE GEBIEDEN IN APELDOORN MOETEN MET VOORRANG WORDEN AANGEPAKT?
Gemeenteraad spreekt zich uit over ruimtelijke opgaven
door Marc Looijen
Met de notitie ‘Stadmaken op
brengt
Daarbij gaat het om vragen als ‘welke gebiedsontwikkelingen het eerst moeten worden opgepakt’ en ‘waar met voorrang ambtelijke capaciteit en middelen op moeten
worden ingezet’. De focus wordt gelegd op drie gebieden: BSK (Binnenstad, Spoorzone en Kanaalzone), de Zuidrand en Uddel. Alle drie zijn cruciaal voor de verdere ruimtelijke ontwikkeling van Apeldoorn 2040, omdat hier veel maatschappelijke opgaven samen-
komen: woningbouw, economie, mobiliteit, natuur, water, energie en landbouw. Binnen deze drie gebieden wordt een verdere focus aangebracht en worden cruciale projecten benoemd, zoals de ontwikkeling van Veldhuis en Kayersmolen-Noord in het BSK-gebied

en de ontwikkeling van de Ecofactorij II in de Zuidrand. En wat nodig is om deze ontwikkelingen voor elkaar te krijgen, zoals bijvoorbeeld een tunnel voor de ontsluiting van de Ecofactorij II en ruimte voor natuurcompensatie. Ook is er aandacht voor stikstof.
‘Wijken met meeste Apeldoorners verdienen meer aandacht’
Bouwien ten Bokum, fractievoorzitter voor D66 Apeldoorn, vindt de doorontwikkeling van de stad belangrijk en nodig. “De Binnenstad, de Spoorzone en de Kanaalzone gaan echt de stedelijke reuring geven, die bij een stad van het formaat Apeldoorn hoort.” Ten Bokum heeft ook een aantal punten van kritiek op het Positionpaper ‘Stadmaken op de Veluwe’, waarin het college de prioriteiten voor de komende jaren benoemt: “De wijken waar de meeste Apeldoorners wonen verdienen wel wat meer aandacht.”
“Het gebied rondom het station en het Kanaal is nu nog redelijk onontdekt, maar dat gaat hopelijk de komende jaren snel veranderen. Sommigen moeten daaraan wennen en vrezen dat de hoogte van de gebouwen de identiteit van Apeldoorn aantast. Er zijn ook positieve reacties zoals: ‘wil men nou
Martin Fransen, raadslid voor het CDA Apeldoorn, benadrukt rond het onderwerp ‘Positionpaper Stadmaken op de Veluwe’ meteen dat hij en zijn fractie tevreden zijn over de Omgevingsvisie, die raadsbreed werd onderschreven en dus ook door zijn fractie. “Wat dat betreft is er met dit document ook weinig nieuws onder de zon, maar nu het college uitvoering geeft aan deze visie, willen wij wel graag aanstippen wat voor het CDA hierin van groot belang is.”


“Alles begint voor ons met de vraag: wat voor stad wil je als Apeldoorn zijn? Wat is het DNA van Apeldoorn? Het CDA streeft naar een gezonde en veilige omgeving waar mensen graag wonen en werken. Woningbouw is wat ons betreft meer dan het stapelen van stenen. Wij willen dat mensen elkaar ontmoeten in een fijne, groene omgeving. De grote uitdaging is: hoe kunnen we dat DNA van Apeldoorn behouden en toch voorzien in de noodzakelijke groei.”
eens
Ten Bokum: “Identiteit van een stad is voor iedereen
anders. Ik vind dat Apeldoorn vooral een inclusieve stad moet zijn, waar mensen met verschillende achtergronden en verschillende
interesses elkaar tegenkomen. Dat gebeurt juist in zo’n gebied als de Binnenstad, Spoorzone en Kanaalzone, met écht stedelijke bebouwing tussen de authentieke industriële gebouwen, waar wonen, werken, uitgaan en studeren zich mengen. Mijn oproep daarbij: Gemeente, hou die woningen ook écht betaalbaar, bijvoorbeeld door casco op te leveren, zodat mensen zelf kunnen afbouwen, dat past in zo’n sfeer. En dan liefst met biobased materialen, zoals hout van onze eigen Veluwe.”
Als je gaat prioriteren, betekent het ook altijd dat er dingen blijven liggen. Ten Bokum vindt dat het in ieder geval niet ten koste mag gaan van de wijken. “In wijken zoals De Maten, Zuid, Orden en Zevenhuizen wonen mensen al vaak jaren en naarmate ze ouder worden krijgen ze een andere woonbehoefte. Ook staan
soms winkels in wijkwinkelcentra leeg en is de openbare ruimte wat sleets geworden. De komende jaren staat er veel te veranderen. Denk aan het gasloos maken van alle woningen en het elektrisch worden van alle auto’s. Daarvoor moeten de wegen open, moeten er laadpalen komen en extra trafohuisjes. De openbare ruimte moet worden vergroend, zodat hitte- en wateroverlast worden tegengegaan. Dat vraagt óók veel investeringen en menskracht.” Ten Bokum pleit ervoor om deze opgaves niet als ‘erbij’ te zien, maar daar volop aandacht voor te hebben. “Als je naar al die opgaves slim in samenhang kijkt, dan zijn er kansen; dan kun je bijvoorbeeld andere type woningen toevoegen of hier en daar wat vervangen, zodat mensen in hun eigen fijne wijk kunnen blijven wonen.”
Ten Bokum heeft nog wel meer aandachtspunten.
“Bouwers hebben moeite om voldoende personeel te vinden en de prijs van materialen rijst de pan uit. Star vasthouden aan een lijst prioriteiten werkt dan niet. Het is belangrijk dat de gemeente slim blijft inspelen op dat wat zich voordoet en tegelijkertijd wél het doel goed voor ogen houdt. Zoals nu bij de Oranjerie, die gaat worden verbouwd tot woningen. Die kans kwam redelijk onverwacht.”
Over het Centraal Beheergebouw zegt Ten Bokum: “We hebben als D66 echt wel begrip voor de ingewikkeldheid, maar het kan echt niet dat deze plek, zo prominent in onze stad, al zoveel jaar leeg staat, verloedert en onveilig is en er keer op keer geen haalbare invulling wordt gevonden. De plannen die ik nu heb gezien zagen er goed uit. Dan zeg ik: hup, en nu aan de slag ermee.”
Op de vraag waar de woningbouw dan voorrang moet krijgen, zegt Fransen resoluut: “Wij vinden het goed dat aan de Zuidrand van Apeldoorn nieuwe woonwijken verrijzen, maar a priori zeggen wij ook: eerst de stad afmaken, maar wel met behoud van ons groene DNA.
De bouwplannen voor het centrum - de Binnenstad, Spoor- en Kanaalzone (BSK) - en de Zuidrand moeten naar onze mening parallel worden aangepakt.” Fransen spreekt van een ambitie die wel onder druk staat, mede door ontwikkelingen zoals stikstof, het niet kunnen
leveren van energie door energiebedrijven, een koopmarkt die steeds meer onder druk staat, oplopende rente en het tekort aan materialen. “De ambitie is ook om 80 procent van de woningen in de BSK-zone in het goedkope- en middensegment te bouwen, hetgeen een forse financiële investering vraagt. Bovendien zie je dat gemeenten en ook Apeldoorn moeilijk aan goed personeel kunnen komen. Om al deze redenen zullen we prioriteiten en focus moeten aanbrengen. Het college neemt de raad daar nu in mee. In ieder geval kan de gemeente het niet alleen, maar hebben we ook woningbouwverenigingen en marktpartijen hard nodig.” Voor wat betreft de woningbouw aan de Zuidrand wil Fransen benadrukken dat de snelweg zo min mogelijk een fysieke barrière mag zijn. “Veel mensen die in het nieuwe woongebied gaan wonen, gaan voor werken, sporten en andere voorzieningen naar de andere kant van de snelweg. Laten we op zoek gaan naar creatieve
oplossingen om voor een optimale verbinding te zorgen.”
Het betrekken van inwoners bij al deze plannen is belangrijk voor het CDA. Dit wordt volgens Fransen onvoldoende in de collegestukken belicht. “Het komt weleens voor dat bewoners te laat betrokken worden bij het maken van plannen. Ook de raad wordt daar vervolgens te laat mee geconfronteerd. Op het moment dat de raad kaders en uitgangspunten meegeeft, moeten de wensen en ideeën van inwoners daarin meegenomen worden. Het CDA heeft hier recent in de raad nog aandacht voor gevraagd.” Fransen realiseert zich dat de ontwikkelingen die op plekken zeer fors zullen zijn, zoals in de Binnenstad, Spoor- en Kanaalzone, niet iedereen blij zullen maken. “Maar luister naar onze bewoners en neem vervolgens als raad je verantwoordelijkheid en leg uit waarom je bepaalde keuzes maakt.” De bestaande wijken en dorpen mogen we
niet uit het oog verliezen.
In dat kader vraagt Fransen aandacht voor BeemteBroekland, waar in grootschalige opwek van energie wordt voorzien. “Al eerder is in de de raad een motie aanvaard, ingediend door het CDA, om integraal te kijken naar het gebied, want Beemte-Broekland is meer dan alleen een zonnepark. Ook hier weer samen met de bewoners: dit moet altijd het uitgangspunt zijn!”
Agenda
Gemeenteraad
donderdag 8 december
19.00 uur

- Dorpsbezoek Loenen (Dorpshuis Loenen, Hoofdweg 5)
- Onderwijsveld (Veluws College Cortenbosch, Waleweingaarde 103, Apeldoorn)


Meer informatie: www.apeldoorn.nl/ gemeenteraad

2
de Veluwe; onze ruimtelijke focus voor de komende jaren’ (positionpaper)
het college prioritering en focus aan in de ruimtelijke opgaven uit Apeldoorn 2040, de omgevingsvisie en het coalitieakkoord. Er worden geen ambities geschrapt maar er wordt geprioriteerd en getemporiseerd voor de komende jaren.
buiten de dorpse box gaan denken’.”
‘Wonen en werken in een fijne, groene omgeving’
Slam poetry en film

surrealistische visuals van special effects-expert Eggert Ketilsson (Batman Begins, Interstellar).
Tien jaar Cultuur bij je buur
Vrijheid van meningsuiting is een universeel en urgent onderwerp en staat wereldwijd onder druk. De derde uit de reeks van acht Movies that Matter On Tour-films maakt pijnlijk duidelijk hoe deze vrijheid wordt gemanipuleerd en politiek onderdrukt. De orwelliaanse speelfilm Erasing Frank (diverse filmprijzen) speelt zich weliswaar af in 1983, maar is nog steeds een actueel verhaal. De voorstelling wordt gepresenteerd op dinsdag 13 december om 20.00 uur in GIGANT, Nieuwstraat 377. Te gast is visueel audio kunstenaar René van Commenée, die het programma start met een eigenzinnig slam poetry optreden.
Erasing Frank


Frank is de charismatische zanger van een verboden punkband, die de stem van zijn generatie vertolkt in opstand tegen het Hongaarse totalitaire regime. In een poging hem het zwijgen op te leggen wordt hij gearresteerd en op de ‘open afdeling’ van een inrichting geplaatst. Erasing Frank is de collectieve
nachtmerrie over vrijheidsbeperking en het onder het tapijt vegen van subculturen. Filmmaker Gabór Fabricius baseerde zich op de talloze getuigenissen van intellectuelen en kunstenaars die (net als de fictieve hoofdpersoon Frank) terechtkwamen in gevangenissen en psychiatrische ziekenhuizen. Geschoten in korrelig zwart-wit met
René van Commenée (foto) De in Apeldoorn woonachtige muzikant en beeldend kunstenaar René van Commenée combineert zijn talenten in geluidskunstinstallaties. Daarnaast maakt hij theaterproducties, werkt samen met toonaangevende artiesten en schrijft muziek voor theater en film. Met zijn op zangteksten gebaseerde project Mr Averell verwierf hij internationaal bekendheid als theatraal performer. In 2023 komt zijn nieuwe duo-album met de legendarische Britse saxofonist/fluitist David Jackson uit.


Een still uit de film Erasing Frank.


Tickets zijn te koop bij GIGANT, online via www. gigant.nl of aan de balie. Telefonisch reserveren kan ook: 055-5216346.




Kerstwijkfeest Berg en Bos
De kerstdagen staan voor de deur en dat viert de wijkvereniging Berg en Bos samen met de bewoners van de wijk, maar ook andere Apeldoorners. Op zaterdag 17 december van 10.00 tot 20.00 uur verandert het schoolplein van de Berg en Bosschool, Soerenseweg 105, in een winterwonderland.




Er zijn activiteiten voor jong en oud, een echte
schaatsbaan en natuurlijk Glühwein en lekkers. De kerstman komt langs in zijn arrenslee en gaat graag met bezoekers op de foto. Het mooiste kersthuis van de wijk en de beste kerstFoutfit vallen in de prijzen. Deelname aan alle activiteiten is helemaal gratis.
In aanloop naar kerst is het natuurlijk fantastisch om de huizen in Berg en Bos te zien veranderen in mooi
Hallo, daar ben ik weer
Deze krant is namelijk gedrukt op gerecycled papier

versierde kersthuizen. Een jury van kerstsfeerexperts gaat vrijdag 16 december de wijk door om het mooist versierde huis op te sporen. De winnaar wordt op het kerstwijkfeest op 17 december in het zonnetje gezet. “Wil je jouw huis opgeven of een ander mooi huis in de wijk? Stuur een mailtje naar secretariaat@ wijkbergenbos.nl en dan komt de jury ook bij jouw huis langs.”

In het weekeinde van 15 en 16 april 2023 vindt de tiende editie van Cultuur bij je buur plaats in Apeldoorn. Voor deze jubileumuitgave worden extra festiviteiten georganiseerd. In talloze huiskamers, tuinen, galeries en wijkcentra treden diverse acts en artiesten gratis op. Het publiek kan, zonder een kaartje te kopen, genieten van optredens en voorstellingen op bijzondere locaties. De werving van artiesten is onlangs van start gegaan.
Artiesten kunnen zich op de website inschrijven tot 1 april. “De belangrijkste voorwaarden zijn dat je een link hebt met Apeldoorn en minstens een half uur kunt vullen met jouw kunstvorm. Vanaf 1 februari kun je geboekt worden door inwoners van Apeldoorn om bij hen drie keer een half uur op één of twee middagen op te treden. Samen maak je verdere afspraken over het optreden en het werven van bezoekers. Aanmelden kan op www.cultuurbijjebuur.nl/ikben-artiest.”


Wie kan er meedoen, wanneer ben je een ‘artiest’? “Cultuur bij je buur is een prachtige
kans voor de beginnende creatieveling, maar is er ook voor de meer ervaren artiest. Het is een gelegenheid om solo of samen met anderen te laten zien of horen wat je te bieden hebt: pop-, rock, jazz- of klassieke muziek, koren, gedichten, verhalen, theater, zang, schilderijen, noem het maar op. Meld je aan en doe mee aan deze extra feestelijke, tiende editie. Voor meer informatie: www.cultuurbijjebuur.nl”
Vergunningen verleend Apeldoorn

- Zutphensestraat 228, formaliseren van gebouwen (wegensteunpunt Rijkswaterstaat)
- Burg. Tutein Noltheniusln 54, plaatsen van zonnepanelen
- Tannhauserstraat 399, kap van een boom - Staalweg 23 en 25, plaatsen dakkapel op achterdakvlak
- Koninklijk Park 16 (Amersfoortseweg zijde), vervangen van toegangspoort
- Marktplein 33, plaatsen van gevelreclame
- Mr. van Rhemenslaan 7, plaatsen van veranda - Wieselse Kampweg 49, Wenum Wiesel, kap van 4 fijnsparren
- Marchantstraat (nabij huisnr. 55), kap van een eik

- Burg. Tutein Noltheniusln 4, restaureren en verduurzamen woning en herinrichten tuin Acacialaan 6, kap van een gleditsia
Vergunning geweigerd Apeldoorn

- Lijsterbeslaan 6, kap van een acacia

Vergunningen aangevraagd Apeldoorn
- Nijbroekseweg 34, wijzigen van verleende vergunning
- Schumanpark 43, plaatsen van een inbraakinstallatie - Vlierbessenlaan 31, plaatsen van een dakkapel - Molenstraat-Centrum 355, aanbrengen balkonbeglazing
- Hoog Soeren naast nr. 18A, Hoog Soeren, oprichten van een woning - Archimedesstraat 2, het vergroten van een woning
Uitgeverij Stedendriehoek
door materialen te gebruiken die
Rodi Rotatiedruk werkt milieuvriendelijk
Uitgeverij Stedendriehoek draagt zorg voor onze wereld door materialen te gebruiken die het milieu zo min mogelijk belasten. We gebruiken 100% gerecycled papier voor het drukken van onze kranten. Verder streven we naar verantwoord gebruik van grondstoffen. Certificaten vindt u op: www.bduprint.nl







Deze krant is gedrukt op gerecycled papier www.stedendriehoek.nl


Bekendmakingen Gemeente 3 M P ...omdat de h inn ing blijft Bezoekadres: Koningslijn 3 | Apeldoorn | T. 055 - 5760585 info@hoogenberg-wegerif.nl | www.hoogenberg-wegerif.nl Openingstijden: ma. t/m vr. 9.00-17.00 u. en za. 9.00-14.00 u. - meer dan 300 monumenten ter inspira�e in onze modeltuin - veel klassieke monumenten in diverse steenkleuren - uit voorraad leverbaar KLASSIEK MONUMENT
Deze krant
gerecycled papier www.stedendriehoek.nl M Nieuwsblad-Stedendriehoek N @Stedendriehoek - P Stedendriehoek
is gedrukt op
M Nieuwsblad-Stedendriehoek N @Stedendriehoek - P Stedendriehoek Uitgeverij Stedendriehoek draagt zorg voor onze wereld door materialen te gebruiken die het milieu zo min mogelijk belasten. We gebruiken 100% gerecycled papier voor het drukken van onze kranten. Verder streven we naar verantwoord gebruik van grondstoffen. Certificaten vindt u op: www.bduprint.nl
onze wereld
het milieu zo min mogelijk
en verantwoord. Waterless Printing, ISO 14001 Grafimedia en KVGO. Dit krantenproduct is geproduceerd door Rodi Rotatiedruk onder gecontroleerde omstandigheden conform ISO 14001 Grafimedia getoetst door de SCGM, Certificaatnummer SCGM-MZ:2011.01.02 Rodi Rotatiedruk werkt milieuvriendelijk en verantwoord. Waterless Printing, ISO 14001 Grafimedia en KVGO. Dit krantenproduct is geproduceerd door Rodi Rotatiedruk onder gecontroleerde omstandigheden conform ISO 14001 Grafimedia getoetst door de SCGM, Certificaatnummer SCGM-MZ:2011.01.02 Bescherm de natuur in Nederland! Word nu lid op natuurmonumenten.nl en ontvang 4 x per jaar het magazine Puur Natuur
draagt zorg voor
belasten.
Tandprothetische praktijk de Veluwe
François (32) opent Tandprothetische praktijk de Veluwe aan de Sprengenweg 28-30 in Apeldoorn.

Met een Veluws concept van Willemijn (26) brengen ze samen sfeer in de praktijk, waar uw kunstgebit op maat en naar wens wordt aangemeten en vervaardigd.
patiënten zonder doorverwijzing van de tand arts bij hem terecht kunnen voor het aanmeten en vervaardigen van een kunstgebit. ‘Het mooiste aan dit vak vind ik dat ik zelf het kunstgebit aanmeet, vervaardig en plaats’, ver telt hij enthousiast. François leert u graag per soonlijk kennen. Zo weet hij wat uw wensen zijn en wat bij u past. Op deze manier heeft hij een betere controle over de esthetiek en kwali teit. Dit resulteert in een mooi en goed functio nerend kunstgebit. Een tevreden patiënt is voor hem het belangrijkste.
proberen ze zo open mogelijk te werken. Er is daarom een raam in de techniekruimte, waar door u naar binnen kan kijken. Ook daar staat de deur altijd voor u open. Er is een mogelijkheid om geld te doneren aan het Hoge Veluwe Fonds; met als doel het in zelfstandigheid behouden van natuur, kunst & architectuur op de Veluwe.
Duurzame reiniging
François is opgegroeid op Aruba, waar zijn ouders een eigen praktijk runden in de tand techniek. ‘Als jong jochie was ik al aan het knut selen met de tanden en kiezen bij mijn vader op de praktijk’, vertelt hij enthousiast. De liefde voor het vak is als het bruisende zeewater op Aruba, het dooft nooit.
Sinds zijn zestiende woont François in Nederland. Nog steeds had hij het doel voor ogen: ik ga later een eigen Tandprothetische praktijk openen. Een lange weg van tien jaar stude ren en werken voor de toen nog jonge onderne mer. Vier jaar volgde hij de opleiding tandtechniek, twee jaar de oplei ding klinisch prothese technieker en vervolgens vier jaar de opleiding tot Tandprotheticus aan de
Hogeschool Utrecht.
‘Ik leer u graag persoonlijk kennen. Zo weet ik wat uw wensen zijn en wat bij u past. Op deze manier heb ik een betere controle over de esthetiek en kwaliteit.’
In 2012 heeft François zijn diploma tandtech niek behaald. Vier jaar later begon hij aan de opleiding tot klinisch prothese technieker. Na het behalen van deze opleiding, had hij de ken nis in huis om onder toeziend oog van de tand arts patiënten te kunnen behandelen. Zo gedreven als hij is, won hij in 2017 de Hammond prijs, als beste leerling klinisch prothese technicus. Hij ging aan de slag als zzp’er bij verschil lende tandartspraktijken.

‘Als jong jochie was ik al aan het knutselen met de tanden en kiezen bij mijn vader op de praktijk.’
Willemijn is de praktijkmanager van Tandprothetische praktijk de Veluwe. Zij staat voor u klaar als u vragen heeft, een afspraak wil inplannen of gezellig een praatje wil maken. Willemijn is opgegroeid op het platteland en legt als docente biologie haar groene ondernemers hart in de praktijk, met oog voor alle patiënten. Het Veluwse concept brengt zij onder andere tot leven door haar schilderingen onder de bedrijfsnaam Decoratieparadijs, dat zij met haar vennoot runt. Deze schilderingen zijn te vinden door de prak tijk. Samen met François zorgt Willemijn voor een fijne Veluwse beleving voor de patiënt, waarbij persoonlijke aandacht op één staat.
We willen dat u zich thuis voelt, want alleen dan kunt u met onze adviezen de juiste keuzes maken met betrekking tot uw kunstgebit. Waar kan dat beter dan op ‘de Veluwe’?
Het reinigen van een kunstgebit hoort niet met tandpasta, omdat hier kleine korreltjes in zitten, wat het kunstgebit kan beschadigen. Dit zorgt ervoor dat bacteriën makkelijker blijven hech ten aan het kunstgebit. Er zijn verschillende speciale kunstgebitreinigers te koop, maar daar zitten bijna altijd chemische stofjes in wat niet ten goede komt aan uw kunstgebit, uw gezondheid en de natuur. Willemijn heeft in samen werking met Blokzeep een speciale zeep laten ontwikkelen, waarmee het kunstgebit gereinigd kan worden. Geen chemische middeltjes, maar natuur lijke ingrediënten! U krijgt de duurzame reinigingset standaard na het plaatsen van een nieuw kunstgebit.
Samenwerken met lokale ondernemers/zorginstellingen
Als kers op de taart start te hij in 2018 de vervolgop leiding tot Tandprotheticus.
Met ruim vijftien jaar erva ring als tandtechnieker en klinisch prothese technieker vliegt hij nu als tandprotheticus uit naar zijn eigen praktijk in Apeldoorn, waarbij
Veluwse sfeer in de praktijk François en Willemijn vinden de sfeer in de praktijk belangrijk. ‘We willen dat u zich thuis voelt, want alleen dan kunt u met onze advie zen de juiste keuzes maken met betrekking tot uw kunstgebit. Waar kan dat beter dan op ‘de Veluwe’?’ aldus Willemijn. In de praktijk komt u dan ook elementen van natuurgebied de Veluwe tegen. Neem een kijkje in de techniekruimte, waar uw kunstgebit wordt vervaardigd. In de praktijk
Wanneer u met een mooi vervaardigd kunstge bit naar buiten loopt, krijgt u een pakje typische Veluwse koek mee. Namelijk; de Apeldoornse Moppen door bakkerij de Ochtendstond. De bakkerij aan de andere kant van de Spreng. De knapperige Apeldoornse Moppen zijn de per fecte test voor het nieuwe kunstgebit!
Daarnaast zetten François en Willemijn zich graag in voor de bewoners in de buurt. ‘Wilt u met ons samenwerken of heeft u een leuk idee? Neem dan contact met ons op.’ vertelt Willemijn enthousiast.

Open dag
Op zaterdag 17 december tussen 12.00 uur en 16.00 uur opent de praktijk zijn deuren voor een Open dag. Iedereen is welkom voor een kijkje in de praktijk. Kom alles te weten over de praktijk onder het genot van een hapje en een drankje! Hoe wordt een kunstgebit gemaakt? Welke Veluwse elementen zijn te vinden in de praktijk? Hoe ligt de stoel in de behandelkamer? Hoe smaakt de koffie in de wachtkamer? Waarom zijn François en Willemijn zo dol op de Veluwe? Maar bovenal; raad de prijsvraag en win een taart van Bakkerij de Ochtendstond en echte Veluwse kersenlikeur ‘Puur smaack’ van de slijterij ‘t Okshoofd!
Volg deze gedreven ondernemers op Socialmedia voor de laatste tips en weetjes over uw kunstgebit èn de praktijk. Instagram, Facebook of LinkedIn. www.kunstgebitveluwe.nl @kunstgebitveluwe Tandprothetische praktijk de Veluwe | Sprengenweg 28-30, 7314ET Apeldoorn | 055-3016235 | welkom@kunstgebitveluwe.nl
Stadhuis open voor schrijfactie Amnesty Apeldoorn
iedereen aan mee kan doen. Amnesty rekent op een grote opkomst deze dag.
APELDOORN - Op zaterdag 10 december, de Dag van de Mensenrechten, is het stadhuis van Apeldoorn van 14.00 tot 21.00 uur open voor de grote schrijfactie Write for Rights van Amnesty International. Iedereen is welkom om een of meerdere brieven of kaarten te komen schrijven voor mensen die ten onrechte zijn vastgezet. Ook kinderen zijn van harte welkom; zij kunnen een tekening maken voor gevangenen.



Er zijn muziekoptredens, gedichten, sprekers, expo sitie en kramen met infor matie en verkoopmateri aal van Mondial-partners,



goede-doelenorganisaties. Bezoekers worden voorzien van drankjes en lekkers. Van 17.00 tot 20.00 uur is er buiten een fakkelwake waar
Vijftig jaar inzet Op 10 december is er ook aandacht voor het 50-jarig jubileum van de werkgroep Apeldoorn van Amnesty International. Sinds de oprich ting in 1972 komen de leden in actie voor wereldwijde mensenrechtenschendingen. Dit doen ze onder meer door het organiseren van (schrijf) acties, gastlessen te geven op scholen en door Movies that Matter-films te verto nen in GIGANT. Het team Apeldoorn bestaat momen teel uit vijftien gemotiveer de mensen en kan heel goed extra vrijwilligers gebruiken. Meer informatie is te vin den op de website www. amnestyapeldoorn.nl.





Schrijfactie Write for Rights Op 10 december, de Dag






van de Rechten van de Mens, worden wereldwijd schrijfac ties georganiseerd. Dit jaar kunnen er kaarten en brieven geschreven worden voor ver schillende mensen die gevan gen zijn genomen nadat ze vreedzaam hebben gepro testeerd voor de mensen rechten in hun land. Zoals voor Dorgelesse Nguessan uit Kameroen, die vijf jaar gevangenisstraf kreeg omdat


Iconen en spiegelbeelden in dok zuid
APELDOORN - Met beide benen op de grond of in hogere sferen: de nieuwe expositie Kunst in dok Zuid is op verschil lende manieren te beleven. Vanaf deze week tot en met 13 januari 2023 bekijk je er iconen en ander werk van Toos Tijink en gespiegelde beelden van de werkelijkheid, vastgelegd door leden van Amateur Fotografen Vereniging De Veluwe (AFV). De expositie is te zien tijdens reguliere openingstijden. De toegang tot dok Zuid, 1e Wormenseweg 460, is gratis.

Toos Tijink is in 1993 begon nen met schilderen in olie verf. De laatste tien jaar werkt ze met acryl. Ze is altijd lessen blijven volgen. Daarnaast heeft Toos een
periode iconen geschilderd. Op de traditionele manier, waarbij op een geprepa reerde houten plaat wordt geschilderd met eitempe ra. Dat is een mengsel van
pigment, eigeel en water. De stralenkrans achter het hoofd van de afbeelding wordt



aangebracht met bladgoud. Het maken van deze van oorsprong religieuze kunst is aan bepaalde regels gebon den.

AFV De Veluwe is een club van ongeveer 50 enthousias te amateurfotografen. Zij zijn verdeeld in drie werkgroepen met elk een eigen interesse gebied: natuur, stad en por tret. Vanuit deze werkgroe pen wordt een jaarprogram ma gemaakt, waarbij leden
ze demonstreerde vanwege de armoede in haar land. Of voor Aleksandra Skochilenko uit Rusland, die gevangen zit omdat ze via prijsetiket ten in de supermarkt informa tie verspreidde over de inva sie in Oekraïne. In het stad huis liggen voorbeeldbrieven klaar die overgeschreven kun nen worden. Kinderen kun nen een tekening maken voor een gevangene. De schrijfac ties hebben geregeld succes: schenders van mensenrech ten worden onder druk gezet, soms verbeteren de discrimi nerende wetten in een land of komen politieke gevange nen vrij.

Jubileumprogramma
Burgemeester Ton Heerts geeft om 14.00 uur het start schot voor de schrijfactie en het jubileumprogramma. Ook Dagmar Oudshoorn, directeur Nederland van Amnesty International,
houdt een toespraak. Samen snijden ze de jubileum taart aan, die gemaakt is door leerlingen van ROC Aventus. Afwisselend zijn er muziekoptredens, gedichten van voormalig stadsdich ters en sprekers. Van tijd tot tijd wordt omgeroepen hoe veel brieven en kaarten er al geschreven zijn.
Verder staat op het pro gramma muziek van de jaren 60 en 70 met Old Friends, gedichten van Herman Kattemölle, de huidige stadsdichter van Apeldoorn, en zijn voorgangers Aad van der Waal en Hanz Mirck.

Het Volverkoor brengt Zuid-Amerikaanse liederen ten gehore en zanggroep Esger klassieke liederen. Tot 21.00 uur is er gelegen heid om het stadhuis bin nen te lopen om een brief of kaart te komen schrijven. De toegang is gratis.
er gezamenlijk op uit trekken om een bepaald onderwerp uit te diepen. Voor deze expo sitie is het thema Spiegelingen bedacht. Een thema waarmee alle werkgroepen aan de slag zijn gegaan. Spiegelingen ont staan op vele manieren, of het nu is via water of bijvoorbeeld de ruit van een museum(café). Deze diversiteit is in de foto’s terug te zien. Voor meer informatie, zie de website www.codaapeldoorn.nl/openingstijden
Vlijtseweg 232A Apeldoorn Tel. 055-3663064 b.g.g. 06-53659359









5
PRODUCT INFO IN DE SHOWROOM ALLEEN OP TELEFONISCHE AFSPRAAK Dé Dakraam specialist PRIJSVOORBEELD 55 x 78 € 755,00 Vraag naar de voorwaarden www.pws-dakramen.nl PWS BOUW S ERVICE vuurwerkvrijapeldoorn.nl Aftellen zonder knallen doen we met z’n allen Gratis enbrengen halen! WWW.MIJNKERSTBOOMAANHUIS.NL Elke dinsdag, donderdag en zaterdag levering aan huis Bestel uw kerstboom snel en eenvoudig op: A-klasse Nordmann Wij levereren uitsluitend de hoogste kwaliteit kerstbomen! Gebruik de code KS10K voor 10% korting De Jonge Hoveniers, Veldkantweg 10a, 6961 HJ Eerbeek Ook te bereiken via WhatsApp 06 51 40 59 95
Check je Zorgpolis vóórdat het jaar 2022 om is! Het kon weer dit jaar, genieten van onze favoriete vakantiebestemmingen! Nederland trok er tijdens de vakanties massaal opuit, waarbij we ook in eigen land maximaal konden genieten van een hele warme zomer. Inmiddels is de herfst in volle gang en kijken we uit naar de stoomboot, de arrenslee en champagne met oliebollen. Misschien hebben wij nog wat leuks voor bij de schoorsteen of onder de kerstboom …


Hoe goed kijk jij naar het jaar 2023? Hoe warmpjes zit jij erbij dit jaar? De kosten voor energie en levensonderhoud rijzen de pan en dat betekent ‘op de kleintjes letten’. Maar dan moet je wel goed kunnen zien!


Daarom hebben wij nog een hele goede tip; check je zorgpolis vóórdat het jaar 2022 om is! Het kan namelijk zijn dat er nog een financiële meevaller op je ligt te wachten. Een vergoeding voor de aanschaf van bril of lenzen.
Goed zien in het nieuwe jaar?



Plan dan je afspraak, gaan we samen kijken naar de mogelijkheden. Heb je vragen? Bel, stuur een email of loop even bij ons binnen.





Linie 385 | 7325 DT Apeldoorn | 055-3010720 info@vanwamelenoptiek.nl | www.vanwamelenoptiek.nl
VAN DE BURGEMEESTER

Veilige stad
Wie het lokale nieuws volgt, heeft zich wellicht de afgelopen maanden wel eens afgevraagd: wat gebeurt er in Apeldoorn? Beschietingen, een ontploffing, overvallen, politie-invallen in woningen, woningen die door mij gesloten werden, het gebeurde inderdaad het afgelopen jaar in Apeldoorn.
Toch ben ik het hartgrondig eens met de politiechef die onlangs vol overtuiging in de krant zei dat Apeldoorn een veilige stad is. Maar dat we wel hard moeten werken om dat zo te houden. Dat is ook precies altijd mijn antwoord als ik die vraag krijg.
Eerst even de feiten: het aantal misdaden in Apeldoorn ligt al jaren onder het landelijke gemiddeld en stijgt ook niet of nauwelijks, neemt zelfs hier en daar af. Dat is dus goed nieuws.
Maar de hardheid ervan neemt wel toe. Dat betekent bijvoorbeeld dat daders jonger worden of sneller een wapen gebruiken. Daardoor kan het lijken dat het allemaal meer wordt, terwijl dat in feite niet zo is. Net als digitale criminaliteit: die heeft vaak enorme impact, omdat het in je huis gebeurt, waar je veilig hoort te zijn.
Plus: een plek kan wel veilig zijn, maar niet veilig aanvoelen. Dat heet subjectieve veiligheid. En dat gevoel heeft veel invloed. Ook waar: als willekeurige inwoner word je zelden of nooit het slachtoffer van een beschieting of ontploffing. Maar het is wel ingrijpend als het in jouw straat gebeurt.
We zijn inmiddels een grote stad, 167.000 inwoners. En helaas zitten daar ook mensen tussen die misdaden plegen. We proberen op allerlei manieren criminaliteit te voorkomen. En als er toch misdaden gepleegd worden, de daders op te pakken en te vervolgen. En dat lukt eigenlijk best goed. Maar helemaal voorkomen en oplossen kunnen we het nooit.
Wat super belangrijk is en blijft: een goede thuisbasis en goed onderwijs. Liefdevol, duidelijk en met de nodige structuur. Dat is en blijft de beste misdaadpreventie. Daarom investeren we ook in jongeren, in ondersteuning van ouders, in onderwijs. Ook ik zeg: Apeldoorn is een veilige stad, waar het fijn wonen, werken, opgroeien en oud worden is. En we doen er alles aan om dat zo te houden. Iedere dag weer.
APELDOORN TELT AF NAAR 2023
GEMEENTENIEUWS
COLOFON
Gemeente Apeldoorn www.apeldoorn.nl www.facebook.com/gemeenteapeldoorn www.twitter.com/gem_apeldoorn Marktplein 1, Postbus 9033 7300 ES Apeldoorn gemeente@apeldoorn.nl telefoon 14 055
Telefonisch bereikbaar van maandag tot en met vrijdag van 8.00 tot 17.00 uur
Publieksbalie
U kunt uitsluitend op afspraak terecht. Wmo-loket voor wonen, welzijn en zorg www.apeldoorn.nl/wmo-loket telefoon 14 055
Telefonisch bereikbaar van maandag tot en met vrijdag van 8.30 tot 16.00 uur
Heeft u de Stedendriehoek niet ontvangen, neem dan contact op met 055-303 49 01.
Op 31 december kunt op drie verschillende plekken in de gemeente Apeldoorn vuurwerk- en/of droneshows bewonderen.


Een goede sfeer, buurtgenoten, stadgenoten en een vuurwerk- of droneshow: alle ingrediënten zijn aanwezig om met elkaar het einde van 2022 en het begin van 2023 te vieren.
Vuurwerk- en droneshows Op 31 december houdt de gemeente vuurwerk- of droneshows in het Zuiderpark, het Zwitsalterrein en in Uddel.
In het Zuiderpark kunt u een droneshow komen bewonderen. U bent van 17.00 tot 19.00 uur van harte welkom, om 18.30 vliegen de dro-
APELDOORN ZOEKT VRIJWILLIGERS

Vrijwilligers: we kunnen niet zonder ze. Vrijwilligerswerk geeft een goed gevoel, leuke en nieuwe contacten en anderen zijn er ook nog eens dankbaar voor.
PLANNING BLADAFVAL OPRUIMEN
Op de website www.apeldoorn.nl/ bladafval ziet u per twee weken waar de gemeente het bladafval opruimt. Van 5 tot en met 9 december gaat de gemeente aan de slag in: Berg en Bos, Winkewijert, Componistenkwartier, Welgelegen Noord, Anklaar, Osseveld Oost, Osseveld West, Lieren, Oosterhuizen, Klarenbeek en Loenen.
Ook in Apeldoorn zijn vrijwilligers nodig. Zo wordt er bijvoorbeeld naar verschillende soorten chauffeurs gezocht. Denk hierbij aan chauffeurs voor de
nes in de lucht. Op het Zwitsalterrein bent u van 20.30 tot 01.00 uur welkom. Om 21.30 uur start daar de eerste vuurwerkshow en om 00.00 uur start de tweede vuurwerkshow. Ook in Uddel, bij het Blanke Schot is een vuurwerkshow. U bent daar van harte welkom van 21.30 tot 23.30 uur. Om 22.30 uur start het vuurwerkspektakel.
Dierenambulance, de Koffiebus en Talma Borgh. Wilt u weten waar uw hulp hard nodig is? Kijk dan eens in de vacaturebank op de website www.apeldoornpaktaan.nl.
EXPOSITIE ‘TOEKOMST BELOFTE’ TE ZIEN IN STADHUIS

JAARWISSELING 2022/2023
Oud en nieuw wordt vanaf dit jaar anders gevierd in Apeldoorn. Want in de gemeente Apeldoorn mag het hele jaar geen consumentenvuurwerk worden afgestoken. Ook niet tijdens de jaarwisseling. Alleen fopen schertsvuurwerk (categorie F1) afsteken mag.
Ook zonder consumentenvuurwerk is oudjaar een gezellig feest, dat u samen viert. De gemeente heeft inwoners en verenigingen uitgenodigd om zelf met voorstellen te komen. Dat kon tot 1 december. Bijna vijftig mensen/verenigingen/organisaties hebben daar gebruik van gemaakt.

Carbidschieten
Wie in het buitengebied of aan de rand van het buitengebied woont, is tijdens de jaarwisseling bekend met carbidschieten. Carbidschieten is toegestaan op oudjaarsdag tussen 10.00 uur en 18.00 uur onder bepaalde voorwaarden. Deze leest u op de website www.apeldoorn.nl/jaarwisseling.
Vuurkorven
Werkt u mee aan een schone en veilige woonomgeving? Laat het de gemeente weten als iets schoongemaakt, opgeruimd of hersteld moet worden. Ligt er bijvoorbeeld een stoeptegel los in uw straat, werkt een lantaarnpaal niet goed of is er iets vernield? U kunt een melding maken bij de gemeente via de website www.apeldoorn.nl/meldingen
De expositie is vrij toegankelijk tijdens de openingstijden van het stadhuis. Berkhout zoekt naar interessante beelden en uitgangspunten in zowel mens, dier als natuur.
Naast categorie F1 vuurwerk, zijn vuurkorven, fakkels en terrashaarden ook toegestaan. Om het gebruik hiervan leuk te houden, zijn er wel wat regels opgesteld. Zo mag uw vuurkorf bijvoorbeeld geen overlast veroorzaken. Gebruik alleen hout wat ervoor bedoeld is en zorg ervoor dat dat kurkdroog is.
Meer informatie
Alle informatie over de jaarwisseling van 2022/2023 kunt u lezen op de website www.apeldoorn.nl/ jaarwisseling.
VOLG DE GEMEENTE VIA SOCIAL MEDIA
• Facebook: gemeenteapeldoorn


• Twitter: gem_apeldoorn
Op de eerste verdieping kunt u de portretten bekijken van de Apeldoornse kunstenares.
Benieuwd naar haar werk? Kom dan snel kijken!
• Instagram: gemeenteapeldoorn
• LinkedIn: Gemeente Apeldoorn



7 DECEMBER 2022
Foto: gemeente Apeldoorn
Ton Heerts
Van 29 november tot en met 27 december is de expositie ‘Toekomst belofte’ van Mirjam Berkhout te bewonderen in het stadhuis.
STOEPTEGEL LOS? MELD HET BIJ DE GEMEENTE
vuurwerkvrijapeldoorn.nl Apeldoorn vuurwerkvrij helemaal het einde
Foto: gemeente Apeldoorn
In 2019 heeft de Hoge Raad bepaald dat een werkgever verplicht is in te stemmen met een be eindigingsvoorstel van een werknemer inclusief transitievergoeding in een slapend dienstver band. Dit omdat deze werkgevers door het UWV gecompenseerd worden voor de transitie vergoeding.

Na deze uitspraak is er veel discussie ontstaan over werknemers waarbij zowel het einde van de wachttijd als de ontslaggrond (langdurige arbeidsongeschikt heid) is gelegen vóór de invoering van de Wet Werk en Zekerheid (WWZ) op 1 juli 2015 (diepslapers) en voor de semi-diepslapers: werknemers waarbij de het einde van de wachttijd is verstreken vóór de WWZ, maar de ontslaggrond is voldragen ná de invoering van de WWZ. Deze werknemers zouden geen recht hebben op een transitievergoeding omdat deze op dat moment nog niet bestond. De Hoge Raad heeft nu bepaald dat werkgevers juist gestimuleerd moeten worden om slapende dienstverbanden te beëindigen. Een werkgever die op of na 1 juli 2015 (invoering WWZ) overgaat tot beëindiging van de arbeidsover eenkomst kan wel aanspraak maken op de compensa tie van het UWV. Wel is door de Hoge Raad aangege ven dat werkgevers alleen hoeven mee te werken aan beëindigingsvoorstellen van de werknemer die op of na 20 juli 2018 zijn gedaan. Een werkgever handelt niet schadeplichtig indien zij niet meewerkt aan een beëindigingsvoorstel door de werknemer vóór deze datum.
Heeft u een (semi-)diepslaper in dienst of bent u een (semi-)diepslaper en heeft u vragen over de beëindi ging van de arbeidsovereenkomst en/of transitiever goeding, neem gerust contact op.






Mr. Sigrid Schinkel schinkel@advocatenkantoorschinkel.nl www.advocatenkantoorschinkel.nl tel: 0570-547120

Van Twickelostraat 13, 7411 SC Deventer
Foto’s van vroeger
APELDOORN - Hij is er weer, de maandkalender van Mannenkoor Bel Canto met oude foto’s van Apeldoorn. Het is inmiddels de 42ste uitgave. Allerlei plekken uit het verleden komen in beeld.

Deze kalender is een must voor degenen die de histo rie van Apeldoorn een warm hart toedragen en graag erva ren hoe het er vroeger uit zag. Een gewild kerstpresent je voor het luttele bedrag van € 5,-. Dit jaar bevat de kalen der onder meer bijgaande foto uit 1948 van ijssalon de IJskoning op de hoek van Hoofdstraat en Kanaalstraatlater was daar de voormalige

V&D. Het was een gezellige drukte op die zonnige dag, zie de vele fietsen. De reclame borden ontlokken een glim lach met een tekst als “H.H.



reizigers hier is gelegenheid uw brood te eten”.
De kalender is te bestellen via telefoon 055-5062817.


Ambulance voor Oekraïne
APELDOORN - Op zondag middag 20 november gaf Oleg Lysenko (zie foto) in de Julianakerk in Apeldoorn een benefietconcert voor zijn thuisland Oekraïne. Dat deed hij samen met zijn accor deon/bayanleerlingen.

De Julianakerk was speciaal voor deze gelegenheid door de gastvrije vrijwilligers inge richt als huiskamer-muziek zaal met fantastische akoes tiek. Mede daardoor kon worden genoten van een prachtig concert, met indrin gende, ontroerende en har monieuze muziek. Uniek en verrassend was het optreden van het eerste Nederlandse Bayankwartet: Oleg Lysenko met drie van zijn leerlingen.

De opbrengst van de kaart verkoop en de nog doorlo pende doneeractie is bestemd voor de aankoop van een ambulance voor de regio Poltava, waar Olegs familie vandaan komt en zijn moe der en broer nog steeds
wonen. De totaalopbrengst van het benefietconcert in de Julianakerk is € 2.488,-. Het doel van de doneerac tie is € 23.000,-. Donaties zijn nog welkom via: www. doneeractie.nl/ambulancevoor-oekra-239-ne/-68066

VOOR 1 JULI 2015 2 JAAR ARBEIDSONGESCHIKT? TOCH TRANSITIEVERGOEDING 8 Omdat elk mens uniek is ’Leg mij maar in de vrije natuur ergens in het gras bij een boompje met een bankje voor mijn vrouw. Is ze toch nog een beetje bij me, zo nu en dan.’ De mooiste uitvaart, is een persoonlijke uitvaart, geregisseerd door Kramer Afscheidshuys Kramer Soerenseweg 71, 7314 JE Apeldoorn Tel. 055-206 99 99 E-mail kantoor@kramerbv.nl www.uitvaartverzorgingkramer.nl
KERKCENTRUM DE DRIE RANKEN Eglantierlaan 202, 7329 AP Apeldoorn 10 december Heeft u oud ijzer waar u vanaf wilt, zoals een oude ets, gootsteen, hekwerk of blik? Door metalen in te leveren bij De Drie Ranken, ruimt u niet alleen de garage op, maar
OUD IJZER KERK ACTIE
levert u ook een nanciële bijdrage aan de kerk. Wij zijn blij met bijvoorbeeld staal, aluminium, rvs, messing, brons, tin, zink, lood en electronica-schroot. Inleveren kan op 10 december tussen 09.00 - 13.00 uur, daarna zorgt Van Gerrevink voor de recycling.
Met hersenletsel in prikkelarme omgeving samenkomen
APELDOORN - Na een val van de trap veranderde het leven van Tamara Neeft uit Eerbeek voorgoed. Ze heeft moeten leren leven met de gevolgen van een flinke hersenkneu zing. Om in contact te komen met lotgenoten met Niet Aangeboren Hersenletsel, startte zij in Apeldoorn de NAH Ontmoetingsochtend.
Bijna twaalf jaar geleden viel Tamara (nu 41) op haar werk van de trap. “Ik rolde hele maal van boven naar bene den, waar ik met mijn hoofd op het beton klapte. Ik bleek een hersenkneuzing te heb ben, met alle gevolgen van dien.” Niet Aangeboren Hersenletsel (NAH), zo luid de de diagnose. Tamara zal de rest van haar leven last hebben van die klap. “Ik heb de hele dag hoofdpijn, wat door extra prikkels kan over slaan in migraine. Ik heb een
slecht geheugen en kan me moeilijk concentreren.” Aan de buitenkant zie je niets aan Tamara. De problemen die ze had met lopen zijn zo goed als weg en ze praat inmid dels weer honderduit. “Ik heb trucjes om mijn beperking te verbergen en ben altijd vrolijk. Maar dat kost alle maal vreselijk veel energie, dus meestal is mijn dag ook
wel voorbij als het avondeten klaar is.”
Onwetendheid
Ook heeft Tamara door de val flink rugletsel opgelopen. Al met al, een hele uitdaging om alles te kunnen doen. Zeker in het begin, toen Tamara meer wilde weten over haar NAH, liep ze tegen onwetendheid aan. “Ik kon weinig informa tie vinden en al helemaal geen lotgenoten in de buurt. Terwijl ik daar wel heel erg behoefte aan had. Bij MEE Veluwe kreeg ik hulp en toen heb ik zelf NAH Ontmoetingsochtenden opgezet voor mensen met (niet) aangeboren hersenlet sel. Het is er prikkelarm voor zover dit mogelijk is - op elk gebouw valt wel wat aan te merken natuurlijk - en geen felle lampen”, legt Tamara uit. “Verder is het gewoon een gezellige ontmoetingsoch tend met heel verschillende
mensen van allerlei leeftijden. Het is fijn om met lotgenoten ervaringen en tips uit te wis selen, maar ook gewoon lek ker om even de deur uit te zijn. Een bezoek aan een café of de bioscoop is voor men sen met NAH meestal niet te doen, dus deze bijeenkomst is ook gewoon een gezel lig uitje. Soms gaat het ner gens over, soms ontstaan er ook heel mooie gesprekken. Maar niets zeggen en alleen luisteren is ook goed.” Ook worden al regelmatig neven activiteiten georganiseerd en komen lotgenootjes ook met leuke ideeën.
Maandelijks bijeen
In Apeldoorn zijn de NAH Ontmoetingsochtenden een feit. De NAH Ontmoetingsochtend is elke tweede maan dag van de maand, van 10.00 tot 12.00 uur in Het Bolwerk (eerste verdieping, kamer 5)
op het adres Ravelijn 55 te Apeldoorn. Deelname is gratis en aanmelding is niet nodig. Iedereen met (N)AH kan zich aansluiten. “Een bege leider meenemen is geen probleem en je kunt tussen 10.00 en 12.00 uur binnen lopen en gaan wanneer je wil”, legt Tamara uit. “We vinden het altijd leuk als er nieuwe mensen komen. Lotgenotencontact is goud waard. De maatschappelijke meerwaarde van lotgenoten contact is enorm. Zelfs werk gevers, verzekeraars, zorg professionals en gemeenten hebben er baat bij.”

Wie vragen heeft, kan voor af wel contact opnemen met Tamara via tammie1981@ hotmail.com/06-33810992. Ook voor vragen met betrek king tot de ontmoetingen in Eerbeek kan men bij haar terecht.

Vivaldi en bekende kerstklassiekers in Grote Kerk
APELDOORN - Beleef in de majestueuze Grote Kerk van Apeldoorn het ultieme concert met kerstklassiekers van wereldberoemde compo nisten. Met in de hoofdrol bij het Classical Christmas Concert pianist Jan Vayne (zie foto) en het beroemde Bach Choir & Orchestra of the Netherlands. Het concert vindt donderdag 15 decem ber vanaf 19.30 uur plaats.
Het programma voor de pauze is een unieke samen smelting van de twee
horen waarom zij tot de top van de Europese barok beho ren. Jan Vayne improviseert in de stijl van Vivaldi zoals hij dat alleen kan: virtuositeit gekop peld aan pure devotie.
Na de pauze worden de bezoekers meegenomen in een totaal andere sfeer met onder andere bekende kerst klassiekers: Silent Night, God rest you merry gentlemen, Last Christmas, Ave Maria en O Holy Night. Geniet van de sprankelende optre dens van solisten: sopraan

Olga Zinovieva, sopraan Eva Schuurman en tenor Martinus Leusink.
De pianovirtuoos Jan Vayne zorgt voor ontroeren de momenten tijdens het Classical Christmas Concert. Wars van vaste gewoonten of muzikale dogma’s improvi seert hij er lustig op los. Wees getuige van de indrukwekken de interactie tussen deze uit zonderlijke pianist en The Bach Orchestra of the Netherlands. Puur, warm en sfeervol in de dagen voor kerst.

Laatste ReparatieCafé van dit jaar
APELDOORN - Donderdag 15 december, van 9.30 tot 11.30 uur, vindt het laatste ReparatieCafé van dit jaar plaats in kerkelijk centrum De Drie Ranken, Eglantierlaan 202. “Kom naar ons toe met huis houdelijke toestellen/appara ten die niet meer werken. Wij denken aan een mixer, fruit pers, snijmachine, (schemer) lamp, koffiezetapparaat, föhn, strijkbout, boormachine, tostiapparaat, gourmetstel, enz. Ook een defect snoertje/stek ker vernieuwen doen we graag voor u”, aldus de organisatie.
“Als het lukt, voorkomen we dat apparaten onnodig op de afvalberg belanden. Ons ReparatieCafé past in het platform ‘Heel Apeldoorn Repareert’. Het lijkt dat het steeds drukker wordt met het repareren, nu de kosten van levensonderhoud exploderen. Het is van de gekke om spul len zomaar weg te gooien, als het nog te maken is. Het is niet duurzaam, want dat afval moet verwerkt worden en er zijn weer grondstoffen nodig voor vervangende apparatuur. Wij zien het als een milieuvrien delijke, laagdrempelige, koste loze hobby, met uitzondering van nieuwe onderdelen. Het geeft u en ons veel voldoening als het lukt. Ons team bestaat uit gemotiveerde, ervaren, vrij willige reparateurs.” Voor het repareren van stofzuigers raadt de organisatie aan naar Foenix aan de Vlijtseweg 136 te gaan. “Daar is een gespecialiseerde reparateur aanwezig.”
9
Beheer Doe mee met de 48ste editie en schrijf je in op midwintermarathon.nl Inschrijven kan tot en met 9 januari. Sponsoren Midwinter Marathon • RunX • de Jong & Laan ondernemende accountants • Uitgeverij Stedendriehoek • Tébé Evenementen Service Partners Midwinter Marathon • Koninklijke Marechaussee • Gemeente Apeldoorn • 123Machineverhuur • Apeldoorn & Bloemzaad Verkeersopleidingen • Theater & Concert Orpheus Vrijdag 3 februari Centraal Beheer Night Run 4 km Zaterdag 4 februari Kroondomein Het Loo Marathon (trail) 42 km Zondag 5 februari Centraal Beheer Kidsrun 1 km / 500 m prestatieloop Decathlon Mini-Marathon 10 em Convins Asselronde 25 km Centraal Beheer Acht van Apeldoorn 8 km Businessrun 10 em | 8 km Meer info: midwintermarathon.nl VOL VOL
Centraal
beroemdste werken die Vivaldi componeerde: het Gloria in D en ‘Winter’ uit De Vier Jaargetijden. Het Gloria in D is het barokgezelschap op het lijf geschreven, waarbij
sopraan Olga Zinovieva en alt Melina Meschkat de schitterende aria’s vertol ken. De musici van The Bach Orchestra of the Netherlands laten in Vivaldi’s ‘Winter’
een vertrouwd gezicht voor al uw vragen
U bent altijd welkom voor een open gesprek.
Bel 055 - 357 44 72 of ga naar monuta.nl/ apeldoorn
DE OUDE OLIFANTENSCHUUR
FRUITBEDRIJF BOUWMAN Bij paleis het Loo.
De hele maand december:
* Stoofperen Gieser Wildeman voor € 1,-/kilo
* Goudreinet voor € 1,-/kilo
Heerlijke ouderwetse APPELBOLLEN van eigen appelen, vers ter plaatse bereid door een echte bakker vanaf vrijdag 16 dec.
Tuinmanslaan 24a in Apeldoorn
woensdag t/m vrijdag van 13.30 tot 17.30 zaterdag van 9.00 tot 16.30 uur
Swingnight bij Boode Bathmen

BATHMEN - Zaterdag 17 december kun je voor alle feestdagen nog even lekker dansen, swingen en uit je dak gaan bij Boode in Bathmen. Doordat ook veel vrienden groepen, clubs, verenigingen en kleine bedrijven hier hun teamuitje afsluiten, is deze laatste Swingnight van het jaar altijd extra feestelijk en goed bezocht.

Bekende Dance-Classics worden door de Swingnight Dj’s afgewisseld met de beste hits van nu, zodat je uren kunt feesten en op de dansvloer losgaan. Tickets à € 10,- zijn zowel online via de website www.swingnight.nl
Bekendmaking

N790; verkeersbesluit traject 37 Wilp – Steenenkamer, zaaknummer 2022-011989
Aanleiding
De provinciale weg N790 verbindt de kernen Voorst, Bussloo, Wilp, Steenenkamer en Deventer met elkaar. De weg sluit bij Voorst aan op de N345 en bij Deventer op de N344. In de bebouwde kom van Wilp sluit de provinciale weg N791 aan op de N790. De N791 vormt de verbinding met de autosnelweg A1, ten westen van Wilp.
Gedeputeerde Staten van Gelderland nemen een verkeersbesluit voor de aanleg van een vrijliggend fietspad tussen Wilp en Steenenkamer, en het verlagen van de maximumsnelheid naar 60 km/uur, op de Wilpsedijk (N790).
Als wegbeheerder van de N790 zijn Gedeputeerde Staten verplicht om voor de beoogde maatregelen op dit traject een verkeersbesluit te nemen.
Ter inzage
Een link naar het verkeersbesluit is vanaf 7 december 2022 te vinden op de website van de provincie Gelderland (www.gelderland.nl-> Bereikbaar Gelderland -> Wegwerkzaamheden -> N790 Wilp – Steenenkamer)
De tekst van het verkeersbesluit is vanaf dezelfde datum ook te vinden op de website van de rijksoverheid (zoek.officielebekendmakingen. nl->Zoek in). U kunt zaaknummer 2022-011989 dan als zoekopdracht ingeven.Tevens ligt een kopie van het verkeersbesluit van 7 december 2022 tot en met 18 januari 2023 ter inzage in het gemeentehuis van de gemeente Voorst.
Instellen beroep

Een belanghebbende die tijdig zijn zienswijze bij de Gedeputeerde Staten naar voren heeft gebracht, alsmede een belanghebbende aan wie redelijkerwijs niet kan worden verweten dat hij niet overeenkomstig 3.4 van de Algemene wet bestuursrecht zijn zienswijze bij Gedeputeerde Staten naar voren heeft gebracht, kan gedurende de bovengenoemde termijn van zes weken na de dag waarop het besluit kenbaar is gemaakt hiertegen beroep instellen bij de Rechtbank Gelderland (Postbus 9090 6800 EM Arnhem) inzake de besluitpunten van het verkeersbesluit.
Diegene die een beroepschrift heeft ingediend kan bij de voorzieningenrechter van de Rechtbank (Postbus 9030, 6800 EM Arnhem) een verzoek indienen om een voorlopige voorziening te treffen. Voor het behandelen van het beroepschrift en voor het behandelen van een verzoek om een voorlopige voorziening wordt griffierecht geheven. Over de hoogte en de wijze van betaling van het griffierecht kunt u informatie verkrijgen bij de rechtbank Gelderland, tel. (088) 3612000 of op www.rechtspraak.nl
Arnhem, 6 december 2022, zaaknummer 2022-011989
Gedeputeerde Staten van Gelderland
als op de avond zelf aan de deur verkrijgbaar, maar kom op tijd want vol=vol… Parkeren kan gratis voor de
Koffiepunten voor de Voedselbank
APELDOORN - De Lionsclub Apeldoorn steekt ook dit jaar Voedselbank Apeldoorn de helpende hand toe bij de lan delijke actie voor het inza melen van Douwe Egberts koffiepunten. De punten worden bij Douwe Egberts verzilverd in pakken koffie voor de voedselbank. In 2020 leverde dit maar liefst ruim 4.000 pakken koffie op. “Tot en met 31 december kunt u uw punten kwijt in de verza melboxen op ruim vijftien loca ties (onder andere supermark ten) in Apeldoorn, Beekbergen en Hoenderloo. Deze loca ties vindt u op apeldoorn. lions.nl en op de website van de Voedselbank. Natuurlijk kunt u uw waardepunten
ook inleveren bij de Lionsclub Apeldoorn, Bosweg 59, en bij de Voedselbank Apeldoorn, Kanaal Noord 147”, aldus Cor van As namens de Lionsclub Apeldoorn.
Waardevol gebaar Stijgende gasprijzen, stijgen de huren en keiharde infla tie, er is een steeds grotere groep mensen die daar last van heeft en mede daardoor onder de armoedegrens leeft. “Gelukkig ondersteunt de Voedselbank wekelijks meer dan tweehonderdvijftig huis houdens met een voedselpak ket. Daar zit niet vaak koffie bij. Hoewel koffie misschien geen primaire levensbehoef te is, mist deze groep mensen hun dagelijkse bakkie koffie
wel degelijk. Een pak koffie (of koffie-pads) in het pak ket is een klein maar waarde vol gebaar.”
Oud en vreemd geld De koffiespaarpuntenactie wordt dit jaar ook gecom bineerd met het inzamelen van oud en vreemd geld. Dit geld wordt omgewisseld in euro’s en voor iedere 10 euro kan in derdewereldlanden een patiënt met staar worden geopereerd. Van As: “Heeft u nog oud of vreemd geld lig gen waar u niets mee doet? U kunt het tegelijk (liefst in een envelop of een zakje) met de koffiepunten inleveren bij de Lionsclub Apeldoorn, Bosweg 59, en bij de Voedselbank, Kanaal Noord 147.”
Deze maand viert fit20 Apeldoorn het 10 jarige lidmaatschap van maar liefst 36 leden! Ja, je leest het goed, er zijn 36 bikkels die al 10 jaar fit20’en. En ze voelen zich er uitstekend bij, fit, energiek, sterk en gezond.
En bij fit20 weten wij natuurlijk wel hoe dit komt. Buiten dat de training die we geven bijzonder effectief is om het lichaam optimaal te laten functioneren, wat wij dagelijks onder onze handen zien ontstaan en dan ook nog wetenschappelijk bewezen is, is de fit20 training een training die je prima vol kunt houden. En daar valt of staat een trainingsresultaat mee. 1x in de week 20 minuten trainen, omkleden is niet nodig (je zweet niet) en je personal trainer
staat op je te wachten, zie dat maar eens over te slaan. Dat doe je gewoon niet. En op deze manier houd je het gemakkelijk jarenlang vol. Geen enkel punt.
Onze 10-jarigen zijn sportievelingen die hun prestaties op het veld, de baan of in de zaal willen verbeteren, het zijn sporthaters die wekelijks een vinkje achter hun ‘sport verplichting’ kunnen zetten, het zijn de drukbezette carrièremakers, tweeverdieners of pensionado’s en het zijn de moeilijke lijven die met klachten of blessures weer op kracht moeten komen. Maar bovenal willen al deze mensen goed voor hun gezondheid zorgen. Fit worden, fit zijn en fit blijven een leven lang. Dat is wat ze willen en dat is waar ze voor gezorgd hebben!
Chapeau! voor al onze fit20’ers en natuurlijk in het speciaal voor onze 10-jarigen namens heel team fit20 Apeldoorn; Astrid, Xandra, Eliana, Jasmijn, Lars, Mike, Christine, Judith, Machanda, Nils & Hilde


- ADVERTORIAL10
deur. De minimumleeftijd is 21+.
De volgende Swingnight bij Boode is op 21 januari.
Wouter Mondeel Apeldoorn
10 jaar fit20 De fit20 training is gratis uit te proberen op 1 van onze 3 locaties in Apeldoorn; fit20 Apeldoorn Noord Boogschutterstraat 1 fit20 Apeldoorn Zuid Oude Apeldoornseweg 43A fit20 Apeldoorn Centrum Asselsestraat 45 055 - 203 41 55 • www.fit20.nl
Hilarische taferelen in afsluitende voorstelling komediereeks
APELDOORN - Harrie Vermeulen, dé creatie van acteur Jon van Eerd, is terug. Dit keer staat een vaderzoonrelatie centraal in de avonturen van het grappigste personage van Nederland. Ook in deze nieuwe voorstel ling trakteert Van Eerd het publiek weer op veel hilari sche avonturen en belevenis sen.
Voor acteur en schrijver Jon van Eerd is zijn creatie van Harrie Vermeulen een voort durende bron van inspiratie. “Vorig jaar in de voorstelling ‘Harrie neemt de benen’ had Harrie een neef. Toen ik die voorstelling aan het schrijven was, had ik al het idee dat het heel leuk zou zijn als Harrie een zoon had”, vertelt Jon van Eerd. “Dan begint het te borrelen en te bubbelen en na anderhalf, twee jaar later is daar de voorstelling Zo vader zo zoon.” Dat schrijven doet Jon veel op de achterbank van de auto. “Tijdens een tournee zijn we natuurlijk veel onderweg en met files hele maal. Ik laat me rijden en kan zo die verloren tijd gebruiken om te schrijven”, vertelt hij.



Diep in het hart Toch komt er een eind aan de avonturen van Harrie. Jon heeft bekendgemaakt na vijf tien voorstellingen te stoppen met de creatie van Harrie. Zo vader zo zoon is dus de laat ste voorstelling rond Harrie Vermeulen. “Na vijftien titels is Harrie Vermeulen toe aan wat rust. Ik zal hem zeker
nooit loslaten, want ik ben hem dankbaar voor wat hij mij en mijn publiek gebracht heeft. Ik zal hem diep in mijn hart meedragen”, aldus Van Eerd. Het afscheid betekent niet dat Jon stopt met the ater maken. Ook voor Jon van Eerd’s Pretpakhuis zal hij zeker actief blijven schrijven en regisseren.
In Zo vader zo zoon woont Harrie in bij zijn succesvol le zoon. Hoe succesvol in zijn werk, in de liefde is zijn zoon een stuk minder handig. Zijn arrogante secretaresse wil hem aan de haak slaan, maar daar steekt Harrie een stok je voor. Hij heeft namelijk een veel lievere vrouw voor zijn kind op het oog. Harrie bedenkt een plan om haar flink te laten blunderen, maar uiteraard laat de dame dit niet zomaar gebeuren en ontstaat er een flinke strijd. Dit resul teert in een reeks hilarische gebeurtenissen, spraakver warringen en intriges. Gaat Harries plannetje werken?

Lezen en schrijven De zoon van Harrie Vermeulen wordt gespeeld door Joey Schalker. Hij is inmiddels een vaste acteur van de Harrie Vermeulen-reeks. Dat geldt ook voor Arie Cupé die vaak van de partij is. Nieuw dit jaar zijn Nandi van Beurden en Susanna Pleiter. Dat Nandi meedoet, heeft niks te maken met haar succes in ‘Op zoek naar’. “Ik zag haar een paar jaar geleden en was gelijk geraakt door haar talent”,
gewerkt heb. Op deze manier schrijf ik een rol die goed bij

en Arie zijn oudgedienden en met hen kan ik inmiddels lezen en schrijven.”
Voor Jon blijft het genre komedie nog altijd bovenaan staan. “Het is vooral de tech niek die me hierin zo aan spreekt”, zegt hij. “Je maakt

direct contact met het publiek en je weet ook gelijk of het aanslaat.”





“En niets is zo leuk als men sen laten lachen. Er even voor te zorgen dat ze hun zor gen vergeten. Als dat lukt, dan ben ik blij. Het moet een feestje zijn, daar gaan we voor.” Zo vader zo zoon is weer anders dan de ande re voorstellingen over Harrie Vermeulen. “Er zitten veel tekstuele grappen in, maar natuurlijk zijn de visuele en absurdistische elementen weer als vanouds aanwezig”, legt Jon uit.
De voorstelling Zo vader zo zoon gaat op tournee door Nederland. De voorstelling is woensdag 22 februari te zien in Theater Orpheus in Apeldoorn.

Kaarten zijn verkrijgbaar via www.orpheus.nl.
Kijk voor meer informatie www.pretpakhuis.nl

Debat over hoogbouw in binnenstad
APELDOORN - Apeldoorn wil groeien naar een stad met ruim 180.000 inwoners en ziet een belangrijk deel van die groei tot stand komen in de bestaande stad. Met name in en rondom het centrum. Maar wat betekent dit voor de bestaande stad? Passen de nieuwe woonmilieus wel bij de gewaardeerde opzet van de stad of kan het elkaar juist versterken? Vanuit de
wetenschap dat er de komen de jaren diverse woontorens zijn voorzien die de hoog te van het kadaster voorbij zullen streven. Dit zal zeker een grote ruimtelijke impact hebben. Het stadssilhouet zal definitief veranderen. Past dit bij Apeldoorn of is dit juist het nieuwe Apeldoorn? Daarom is het hoog tijd voor een debat over de koers van de gemeente die zijn weerslag zal krijgen in de binnenstad


van Apeldoorn, inclusief de Spoor- en Kanaalzone. Actueel daarbinnen is het gepresenteerde Masterplan voor Veldhuis als eerste uit werking daarvan die op de avond zal worden toegelicht en besproken.

Het debat heeft plaats op dinsdag 13 december van 20.00 tot 22.00 uur in het ACEC-gebouw, Roggestraat 44.


Architectuurcentrum Bouwhuis heeft als doelstel ling om het gesprek te orga niseren over de gebouwde stad en nodigt daarom de Apeldoornse bevolking uit om over deze zeer belangrij ke nieuwe ruimtelijke ontwik kelingen mee te denken op dinsdag 13 december.
Het debat wordt geleid door stedenbouwkundige en moderator Henry Huiskamp.
11
vertelt Jon van Eerd. Voor hij gaat schrijven, gaat hij uitgebreid met zijn acteurs praten. “Vooral met Nandi en Susanna waar ik nog niet mee
ze past. Joey
ZUIDBROEK ROYAAL GENIETEN IN APELDOORN Nieuwbouw 8 woningen aan de Terwoldseweg 10 woningen aan de Musicalstraat Stijlvolle architectuur Gasloos, energiezuinig en voorzien van zonnepanelen daardoor een lage energierekening Wonen in een kindvriendelijke wijk Wil jij weten hoeveel je kunt besparen met een woning van Laan van Buiten? Bereken het met de ENERGIETOOL op de website! Sc de QR-c e START BOUW Q1-2023 VERKOOP & INFORMATIE Roggestraat 167, Apeldoorn T 055 - 57 77 107 E info@nieuwbouwcentrumapeldoorn.nl www.nieuwbouwcentrumapeldoorn.nl Comfortabel binnenklimaat Stadsverwarming Bijna energieneutraal Voorzien van zonnewering www.laanvanbuiten.nl Informatieavond Heb je interesse of wil je meer weten? Op DINSDAG 13 DECEMBER is er van 18.00 -19.30 uur een informatieavond bij Nieuwbouw Centrum Apeldoorn. Je bent van harte welkom!

Huurder sloopt eigen appartementengebouw
APELDOORN - De sloophan deling van het eerste flatge bouw werd uitgevoerd door Anita van Haarlem. Zij is één van de oud-bewoners die terugkeert naar een nieuw te bouwen appartement aan de Goeman Borgesiusstraat. In totaal sloopt De Goede Woning 126 appartemen ten en bouwt tenminste 153 appartementen terug.

Anita van Haarlem zegt: “We zijn als huurders vanaf het begin af aan goed begeleid door een vast aanspreekpunt bij De Goede Woning. Vorig jaar september hoorden we dat ons huis gesloopt ging
worden. Er was veel begrip en ruimte om dit nieuws een plekje te geven, daarna kwam berusting en nu richt ik me op mijn nieuwe appartement.
Ik vind het geweldig dat ik vandaag de sloophandeling mocht uitvoeren. Ik heb nog nooit een ruit ingegooid en moet je nu toch eens kijken
wat ik gedaan heb! De hele gevel ligt eruit, fantastisch!”
In totaal sloopt De Goede 126 appartementen en

bouwt tenminste 153 appartementen terug. Het gaat om drie flats aan de Goeman Borgesiusstraat en drie flats aan De Savornin
Lohmanstraat. De nieuw te bouwen appartementen zijn gasloos, energiezuinig en dus klaar voor de toekomst. Op deze manier wil De Goede Woning een bijdrage leveren aan de duurzaamheidsopga ve die er ligt. “Door een extra woonlaag aan te brengen en een andere indeling toe te passen voegen we apparte menten toe aan onze woning voorraad. Hierdoor kunnen we meer woningen verhu ren en een bijdrage leveren aan het terugdringen van het woningtekort”, zegt Rob van Beek, directeur-bestuurder van De Goede Woning.
(Fotografie: Rob Voss)
Wijn proeven na de filmOp de duofiets in Klarenbeek
discipline in het wijnproe ven. Deelnemers proberen te deduceren welke druif ze proeven, uit welk land en streek de wijn komt, uit welk jaar en van welke wijnmaker de wijn is. Uiteraard zijn er mooie prijzen te winnen.
Blind Ambition
APELDOORN - In samenwerking met Vintake verzorgt GIGANT op donderdag 8 december een wijnproeverij bij de film Blind Ambition. Deelnemers kijken eerst de film Blind Ambition en proeven daarna zes geweldige wijnen die door Vintake zijn geselecteerd. Kaarten voor de film en wijnproe verij zijn te koop via www.gigant.nl en aan de balie van GIGANT, Nieuwstraat 377.
Blindproeverij Vintake neemt de deelnemers mee in de wereld van het ‘blind proeven’, de lastigste
Van vluchtelingen tot topsommeliers. De documen taire Blind Ambition vertelt het ongelooflijke verhaal van vier mannen die de interna tionale wijnwereld op zijn kop zetten door als eerste team van Zimbabwe deel te nemen aan de World Blind Wine Tasting Championships, de Olympische Spelen van de wijnwereld. De film is de win naar van de Publieksprijs van het Tribeca Filmfestival.

KLARENBEEK - Sinds kort kan ook Klarenbeek gebruik maken van de duofiets. Gebiedsmanager Harriët Althof van de gemeente Apeldoorn verrichtte de officiële opening door op de fiets plaats te nemen en het eerste ritje te maken.
Met de nieuwe, elektri sche duofiets kunnen men sen die niet gemakkelijk op eigen kracht kunnen fiet sen, toch veilig een fiets tocht maken, samen met een familielid, bekende, of vrijwilliger. Daarnaast biedt de duofiets gelegenheid tot bijzondere ontmoetingen, ook voor wie niet slecht ter been is. De bestuurder stuurt en trapt, en meetrap pen kan naar behoefte en

mogelijkheden. Het pro ject kwam tot stand door inspanningen van velen. De Werkgroep Duofiets kreeg hulp en steun van sponsors,
partners en de gemeenten Apeldoorn en Voorst.
Daarnaast kon de werk groep rekenen op praktische en organisatorische hulp van veel vrijwilligers. Sommigen van hen bouwden een goed onderkomen voor de duo fiets, anderen stelden mate riaal beschikbaar. Weer anderen zullen de uitgifte in goede banen leiden en zor gen dat iedereen met duide lijke instructies veilig de weg op gaat.
De fiets staat bij het Multifunctioneel Centrum (MFC) aan de Bosweg en kan worden gereserveerd via de website van Klarenbeeks Belang: klarenbeeksbelang. nl/duofiets.
KEELPIJN OPGELOST
De periode van keelpijn breekt weer aan. Verminderde weerstand, te lang op de tocht staan, infectie met een ziektekiem en stress kunnen allemaal de oorzaak zijn. Keelpijn kan van de één op de andere dag ontstaan en wordt als zeer storend ervaren. Slikken of praten doet zeer en als je er ook nog bij moet hoesten, is het helemaal vervelend. Maar er zijn manieren om snel van je keelpijn af te komen. Vaak grijpen mensen terug op de vertrouwde adviezen van oma. Ook De Stoelendans heeft een aantal adviezen om er snel weer bovenop te komen.
Veel mensen worden in de winter geplaagd door keelpijn. Meestal is keelpijn het gevolg van een infectie met een ziektekiem (virussen en bacterien). Het afweersysteem reageert daarop met een ontsteking. Soms kunnen die verschillende infecties en ontstekingen samen voorkomen. Wanneer het keelslijmvlies en de amandelen ontstoken zijn, spreekt men van een angina. Die term wordt ook gebruikt voor een infectie van de keel door bacterien (streptokok).
Oorzaken van keelpijn Keelpijn wordt meestal veroorzaakt door een virus, zoals het verkoudheidsvirus. Het verkoudheidsvirus kan ook andere verkoudheidsklachten, zoals een verstopte neus of loopneus, veroorzaken. Als u erge keelpijn heeft, kan dit betekenen dat u een keel-
ontsteking heeft. Stress of angst kan ervoor zorgen dat je, onbewust, de spieren in de hals en keel aanspant. Dit kan een brokgevoel in de keel veroorzaken. Sommige mensen slikken heel bewust speeksel en slijm door dat gedurende de hele dag geproduceerd wordt. Door dit bewust slikken, de hele dag door, kan er ook een brokgevoel of keelpijngevoel ontstaan.
Keelpijn verlichten Keelpijn kan heel vervelend en pijnlijk zijn. Maar wat is nu eigenlijk het beste advies bij keelpijn? Belangrijk is vooral dat je drinkt. Bij kleine kinderen is het zeker belangrijk dat je ze zoveel mogelijk laat drinken. Een koude of warme drank maakt eigenlijk niet zoveel uit, maar vermijd zure dranken. Koude dranken kunnen kortstondig een licht verdovend effect hebben, wat een aangenaam gevoel geeft. Warme dranken zoals soep, kruidenthee met honing en een beetje citroen werken verzachtend en kunnen helpen om slijmen op te hoesten.
Oma weet raad
Het is een typische ‘oma-remedie’: een lepel honing in warme melk of kruidenthee oplossen en met kleine slokjes uitdrinken zou keelpijn verzachten. Maar oma’s advies was blijkbaar nog zo slecht niet, want een Brits onderzoeksteam van de universiteit van Oxford kwam tot de conclusie dat honing effectief

werkt bij een niet al te ernstige keelinfectie van bacteriële aard. Echter, het EFSA heeft geen claim over het eten van honing op de gezondheid goedgekeurd.

De Stoelendans adviseert
De Stoelendans heeft een aantal producten in het assortiment die vooral gebruikt kunnen worden bij, opkomende, keelpijn. Om twee vliegen in één klap te slaan is er CBD honing. Deze honing werkt volgens oma’s advies verzachtend op de keel en helpt bij stresssituaties door een rustgevend effect. Daarnaast zijn er vier soorten CBD thee die ieder een eigen kruidenmix hebben. Zo bevat Relax Citroenbalsem, Kamille en sinaasappelbloesem, Natural een lichte dosis zout, Calm 10% gemberwortel en Inmuno 15% Tijm, 15% Rozemarijn en 12% Oregano. Naast de kruiden is de warme thee verzachtend voor de keel. Ook voor een kruidensiroop of een neusspray biedt ons assortiment een oplossing.
De-Stoelendans.nl • Nieuwstraat 53 • 7411 LH Deventer
Volg en like ons op: facebook.com/De.Stoelendans
13
NIKS INGEVULD? DAN BEN JE DONOR
Heb je niks ingevuld in het Donorregister? Dan sta je erin met ‘geen bezwaar’. Dit betekent dat je organen en weefsels na je overlijden naar een patiënt kunnen gaan. Ontdek welke keuze bij je past. De informatie hieronder helpt je daarbij.
WAT IS ORGAANDONATIE?
Als je overlijdt, kun je een orgaan of weefsel weggeven aan iemand bij wie dat orgaan niet (goed) werkt. Je bent dan orgaandonor.
HOE WERKT ORGAANDONATIE?
Orgaandonatie kan alleen wanneer je in het ziekenhuis overlijdt. Een arts stelt de dood vast. Daar volgen zij regels en afspraken voor. Dit alles bespreekt de arts uitgebreid.
WAT ZIJN DE KEUZES?
Ja, ik wil donor worden. Nee, ik wil geen donor worden.
Ik wijs één persoon aan die beslist na mijn overlijden. Mijn partner of familie beslist na mijn overlijden.
MET WIE KUN JE OVER ORGAANDONATIE PRATEN?
Over donatie praten kan met (bijna) iedereen. Denk aan je partner, familie of vrienden. Maar je kan hier ook over praten met mensen bij het buurt–huis of met de buurtcoach. Is geloof belangrijk voor je? Dan kun je met de voorganger van je geloof in gesprek gaan. Denk aan een imam of priester.
IK KAN NU MIJN KEUZE MAKEN
Log in met je DigiD op mijn.donorregister.nl Of vraag een papieren formulier aan via 0900 - 821 21 66
Je kunt je keuze altijd veranderen.
Meer uitleg nodig? Bel 0900 - 821 21 66, scan de QR-code of ga naar donorregister.nl/keuzehulp
Het einde van 2022 nadert
periode van het jaar zetten we het licht aan in de bin nenstad. Tijdens het eve nement Wintersferen wor den de koninklijke verhalen van Paleis Het Loo en de historische verbinding met Apeldoorn via videoprojecties op panden verteld. Op een laagdrempelige en eigentijd se manier, interessant voor zowel inwoner als bezoeker.
sprekers informeerde en inspi reerde Apeldoornse onderne mers in de toeristische sec tor over mogelijkheden tot het verduurzamen van hun eigen bedrijf – en daarmee de wereld. Door om te den ken heeft deze tijd juist voor de toeristische sector veel te bieden om Apeldoorn als dé groene en royale stad op de kaart te zetten.
Claudi Groot Koerkamp Directeur-bestuurder Apeldoorn Partners


De winter doet langzaam z’n intrede en de stad is roy aal aangekleed. Apeldoorn is in het najaar één van de prachtigste plekken om te zijn. Goudgele bladeren zor gen in de bossen en op straat voor een kleurrijke aanblik, avonden vallen steeds vroe ger en restaurants pakken uit met smaakvolle menu’s. In Apeldoorn vind je de rust en ruimte, terwijl je ook kunt genieten van alle stedelijke faciliteiten.
De kortste dag van het jaar - woensdag 21 decembernadert. En in de donkerste
De videoprojecties zijn van 20 tot en met 23 december te zien in de binnenstad, met als kers op de taart een grote videoshow op het stadhuis op 22 december.
Voor Apeldoorn als Royale en Groene stad, is duurzaamheid uiteraard belangrijk voor ons. Zo wordt de sfeerverlichting in de binnenstad eerder uitge zet om energie te besparen. Ondernemers worden door stijgende prijzen van energie en grondstoffen gedwongen op korte termijn na te denken over duurzame alternatieven. Om op weg te helpen, orga niseerde Apeldoorn Partners eind november een bijeen komst gericht op duurzaam ondernemen. Een aantal
Vanuit Apeldoorn Partners kijken we terug op een mooi jaar. Het eerste jaar na onze fusie. Een jaar waar in de kernwoorden ‘groen’ en ‘royaal’ de leidraad vorm den in al onze werkzaamhe den. Een jaar waarin Paleis Het Loo haar deuren open de na een ingrijpende ver bouwing. Een moment waar we reikhalzend naar uitkeken; het jaar 2022 werd gekroond tot Koninklijk jaar en we ont wikkelden samen met part ners een grootscheepse cam pagne. We haalden imagoversterkende congressen binnen, ontwikkelden projec ten om zowel binnenstad als buitengebied extra te profi leren, droegen bij aan een
Fototechniek in NewTechPark
APELDOORN - Donderdagavond 8 december ver zorgt ComputerClub HCC!Apeldoorn een presentatie over diverse fototechnieken.

Een daarvan is: ‘Hoe zorg ik voor de juiste belich ting?’ Veel camera’s hebben tegenwoordig verregaande
techniek, maar dat wil niet zeggen dat iedere foto goed is. “We laten aan de hand van praktijkvoorbeelden zien waar het fout gaat en hoe het veel beter kan,” aldus de organisatie. “Ook is er aandacht voor opnamestand punt, perspectief. Dit moet u zelf zien, de camera kan
dit niet automatisch. Aan de hand van voorbeeldfoto’s zult u het direct herkennen.”
En dan is er nog de vraag: Welke resolutie heb ik nodig? “De term resolutie wordt heel vaak gebruikt in de commer cie. Maar wat is dat eigen lijk? Hoge waarden staan niet gelijk aan een groot beeld.

evenwichtig en krachtig eve nementenbeleid en zetten Apeldoorn zowel regionaal als landelijk op de kaart. Ik wil graag afsluiten met een leuk nieuwtje. Eén om héél trots op te zijn; Apeldoorn staat namelijk in de top 3 gezond ste steden van Nederland! In het onderzoek ‘Gezonde Stad Index 2022’ van Arcadis dat eind november verscheen, wordt onder andere geke ken of een stad buitenruim te biedt die uitnodigt om te gebruiken. Apeldoorn scoort op dat vlak erg hoog, net als op gezond milieu en gezon de gemeenschap. Er is veel groen om in te spelen, wat bijdraagt aan de gezondheid van kinderen. Qua mobili teit kan Apeldoorn nog groei en; de toegankelijkheid voor fietsers, voetgangers en reizi gers in het OV kan beter. Al met al een heel mooie plek voor Gemeente Apeldoorn als groene en royale hoofdstad van de Veluwe! Op naar de nummer 1-positie!
Ik wens u hele fijne feestdagen! Tot volgend jaar.
Wo. 7 en za. 10 en zo. 11 dec.



ZAAG JE EIGEN KERSTBOOM
Wie dit jaar met kerst geen gekweekte spar maar een échte Hoge Veluwse scharrel-den in huis wil hebben, kan terecht in Het Nationale Park De Hoge Veluwe. Op een aangewezen plek in het park mogen alle bezoekers gratis een boom uitkiezen, zagen en meenemen. Eén boom per bezoeker en je draagt een steentje bij aan het behoud van dit bijzondere gebied! Boek vooraf online je gratis tijdslot. uitinapeldoorn.nl/zaag-je-eigen-kerstboom

Iedere wo. t/m zo. in dec.

WINTER BLOTEVOETENPAD


Zo. 11 dec.
RONDLEIDING
scheidt door haar constructieve maatwerkoplossingen op het gebied van efficiëntie en veiligheid voor uiteenlopende toepassingen van equipment, voertuigen, machines en installaties.
Wegens uitbreiding van de werkzaamheden en groei van de organisatie, zijn wij per direct op zoek naar een:
• Financieel/ Administratief
















Medewerker (20 uur)
Voor meer informatie over onze vacatures en werkzaamheden verwijzen wij je door naar www.wiejelo.nl Reageren kan via suzanne.boertien@wiejelo.com
Laan van het Omniversum 20 7324 BM Apeldoorn The Netherlands +31 (0)85 87 85 691 info@wiejelo.com www.wiejelo.nl



De termen DPI en PPI wor den duidelijk gemaakt. We laten ook voorbeelden zien bij een TV, smartphone en megapixels.”




De bijeenkomst vindt plaats van 20.00 tot 22.00 uur op de locatie NewTechPark, Vlijtseweg 148 (ingang Noord). De toegang is gratis.
Ontdek de winter bij Buitenpost en ga op avon tuur op het Blotevoetenpad! Dit hoeft natuurlijk niet op blote voeten; schoenen en laarzen zijn toegestaan bij deze speciale wintereditie. Ga op pad met een zoek kaart en maak kennis met de bijzondere bewoners van Buitenpost. Tijdens de wandeling van ongeveer 2 kilometer kom je sporen tegen van verschil lende dieren die voorkomen op het landgoed. Spot jij ze allemaal? uitinapeldoorn.nl/ vlooienmarkt
RADIO KOOTWIJK MET GIDS
Dompel je onder in de geschiedenis van één van de meest opmerkelijke gebou wen van Nederland: het voormalige zendstation Radio Kootwijk. Deze zon dag kun je het gebouw met Art Deco-architectuur bezoe ken met gids. Ontdek meer over de boeiende historie van het zendstation. Combineer het met een wandeling door de omliggende natuur en breng een bezoek aan de monumentale pomphuisjes. Betaalde deelname. uitinapeldoorn.nl/ radio-kootwijk
Voor een actueel overzicht van alle activiteiten: uitinapeldoorn.nl
15
Uittips deze week
MASTERPIECES.NL • NIEUWSTRAAT 53 • 7411 LH DEVENTER Volg en like ons op: facebook.com/De.Stoelendans en facebook.com/masterpieces.nl MASTERPIECES.NL HEEFT BIJZONDERE HORLOGES IN HAAR ASSORTIMENT
onderneming
Wiejelo Equipment is een dynamische
die zich onder
W
FEB















André Kuipers - Op reis naar de toekomst







Astronaut André Kuipers vertelt aan jong en oud als geen ander over de toekomst van het reizen in de ruimte.


14 FEB






























































































Nederlandse Reisopera - Die Zauber öte Mozarts geliefde operaklassieker in een modern jasje, met een verbluffend decor en uitmuntend muzikaal talent.







































10 & 11 MRT






























A Night at… Las Vegas





































































Een dinnershow waarin je wordt meegenomen in de wereld van roulette, poker en blackjack. Laat jezelf verwennen met hits van o.a. Elvis, Frank Sinatra, Tom Jones en Céline Dion en geniet ondertussen van een verrukkelijk diner.














































orpheus.nl/cadeau
Familiespel - Jacqueline Blom, Mark Rietman, Bas Hoe aak en Annick Boer
Hendrik Groen
Opgewekt naar de eindstreep The Prom - Pia Douwes, Dennis Willekens e.a. Erik of het klein Insectenboek
HNT Jong i.s.m. SSBU
Assepoester de Musical Igone de Jongh - Zin in liefde
-
-
Erik Scherder & Jan Vayne - Science Meets Music
Wolfgang, het wonderjong - Pieter Kramer/Theater Alliantie & Theater Oostpool
In
Jon van Eerd - Zo vader zo zoon
Koning -
Schillen 04 FEB 11 JAN 07 JAN 22 FEB 01 MRT 17 t/m 19 MRT 10 MRT 10 FEB 17 & 18 FEB 01 FEB 22 JAN 4+ 8+ 8+ 05 JAN Before After - Coen Bril en Desi van Doeveren Een intieme musical met live muziek vol meeslepende ballads over liefde, identiteit en het doorbreken van patronen. 06 JAN Johan Goossens - Kleine Pijntjes Een verzet tegen het onvermijdelijke verval met liedjes, verhalen en relativerende humor. 08 JAN Residentie
Een spectaculair feest op het
groots repertoire
Leonard Bernstein, George
Aaron
25 JAN Gelukzoekers
Na het succes
opnieuw
voorstelling
de
02
Edsilia Rombley -
Balans
Martijn
Appeltjes
Orkest - Nieuwjaarsconcert
podium. Uitbundig, met
van
Gershwin en
Copland.
op Sumatra
van De Tolk van Java en Lichter dan ik volgt
een
die de onderbelichte kant van
Nederlandse koloniale bezetting van Indonesië toont.
csv Apeldoorn in laatste thuiswedstrijd van 2022 tegen Buitenpost
door Henk-Jan van Beek





APELDOORN - csv Apeldoorn neemt het in de laatste thuis wedstrijd van dit kalender jaar op tegen Buitenpost. De Friezen staan net als de roodgelen met twintig punten in de middenmoot. Beide ploe gen willen uiteraard graag aansluiten bij de subtop én met een goed gevoel de win terstop ingaan, dus zal het een interessant duel worden op het Orderbos.
Buitenpost, sinds het sei zoen 2018-2019 uitkomend in de vierde divisie B, en csv Apeldoorn staan gedeeld acht ste in de vierde divisie B. Na veertien wedstrijden wonnen beide teams zes keer en werd er even vaak verloren. Het doelsaldo van Buitenpost is -6 (15-21) en van csv Apeldoorn


-7 (20-27). Koploper Eemdijk, met 36 punten en een voor sprong van acht punten op runner-up SC Genemuiden, heeft zes verliespunten. De derde ploeg uit BunschotenSpakenburg liep die nederla gen op tegen csv Apeldoorn (4-2) én Buitenpost (1-0). De
zege van Buitenpost op de eerste dag van oktober tegen Eemdijk deed de blauw-wit ten veel goed. Er werd vervol gens nog vier keer gewonnen, waardoor de noorderlingen de onderste regionen wisten te verlaten. Vorige week zater dag ging het thuisduel met




DETO verloren. Op Sportpark De Swadde werd het 0-1 door een vroeg doelpunt van Kai Wesselink.
Afgelopen week werd bekend dat hoofdtrainer Willem Brouwer aan het einde van dit seizoen stopt. De 59-jari ge coach trainde in het verle den onder andere Flevo Boys, Harkemase Boys en Berkum en is nu bezig aan zijn tweede sei zoen bij Buitenpost. Brouwer wil zijn vrije tijd vooral buiten het voetbal gaan besteden. csv Apeldoorn kreeg vorig week end een forse nederlaag te verwerken. In Aalten werd het 5-0 voor AZSV. De 1-1 van Cem Köse vlak voor rust vond geen genade in de ogen van de assistent-scheidsrechter. Het doelpunt, dat de wedstrijd had doen kantelen, werd afge keurd wegens vermeend bui tenspel. Levi Tuasela kreeg bij

een 3-0 stand een rode kaart. Beide ploegen stonden in het seizoen 2018-2019 al eerder tegenover elkaar. In Buitenpost gingen de Apeldoorners met 2-1 onderuit, maar op het Orderbos werd het 3-1 na een 0-1 achterstand. Maarten Boeve, Maikel Lange en

Fedde Timmer waren die mid dag trefzeker. csv ApeldoornBuitenpost staat onder leiding van scheidsrechter Kiremit en begint om 15.00 uur. De wed strijd wordt gesponsord door Dijkgraaf, totaalleverancier van kantoorartikelen.




Fotografie: Wout van Zoeren.
Oer-Hollandse snert verbindt Apeldoornse 50-plussers
APELDOORN - En dan is het ineens weer december. Korte dagen en lange nachten, guur weer: een maand die niet iedereen even leuk én mak kelijk vindt. De één houdt van de feestdagen, de ander ziet er tegenop. Daarom heeft social app Klup de tweede zondag van december omge doopt tot Nationale Snertdag. Dit jaar betreft een jubile umeditie, aangezien het de vijfde keer is dat het evene ment plaatsvindt.




Uiteraard draait het niet om de snert, maar is het een mooi middel om mensen te verbinden in een maand dat dit juist hard nodig is. Ook in Apeldoorn wordt met twintig deelnemers snert gegeten bij Stayokay Hostel Apeldoorn, Asselsestraat 330. De orga nisatie nodigt 50-plussers uit om deel te nemen aan dit sociale evenement op zondag 11 december. Tijden, loca ties en aanmelden vindt men in de Klup-app en via www. kluppen.nl Klup is een sociaal plat form en heeft als missie om


17
Ruben Katerberg in duel met Chris Verheul van AZSV.
Rik Vlutters in duel met Bram Wansink van AZSV.
Onder het mom van ‘Maak van je Snertdag een Feestdag’ komen op zestig locaties door heel Nederland 50-plusleden van Klup samen om gezel lig een kop snert te eten.
50-plussers in Nederland te verbinden en inspireren om via haar Klup-app activitei ten te ondernemen en samen ervaringen te delen. Wekelijks
|
|
MEER DAN ALLEEN COATING Kijk voor meer informatie op: WWW.KAMPCOATING.NL De schilder die ook binnen alles schildert. Scootmobielen Wij leveren ook gebruikte scootmobielen met garantie. Pijnappel Scoot OOK VOOR: SERVICE, ONDERHOUD EN REPARATIE Anklaarseweg 97A (t.o. Robur et Velocitas) 7317 AS Apeldoorn. Tel. 055 57 88 005 E-mail: info@scoot.nu Meer dan 20 verschillende typen scootmobielen uit voorraad leverbaar vanaf € 895,Kijk ook eens op: www.scoot.nu Ruime parkeergelegenheid www.veenemanbouw.nl Veeneman Bouw wenst csv Apeldoorn veel succes de komende wedstrijd! vuurwerkvrijapeldoorn.nl Wel zo mooi zonder rotzooi
organiseren leden (kluppers) meer dan 300 activiteiten en gebruiken duizenden leden dagelijks de app. POEDERCOATING
NATLAKKEN
VOORBEHANDE LEN
Broekhuis Apeldoorn, nu ook voor Fiat, Jeep en Alfa Romeo


Per 1 december 2022 zijn de activiteiten van De Snipperling Apeldoorn overgedaan aan Broekhuis en zullen de dealerschappen, de diensten en medewerkers zich verplaatsen naar het pand van Broekhuis Opel Apeldoorn.

Dit houdt in dat voor klanten van De Snipperling Apeldoorn de werkzaamheden ondergebracht worden in het pand aan de Laan van Malkenschoten 85, waar nu ook al Broekhuis Opel Apeldoorn gehuisvest is. De gezichten van medewerkers die voor de klanten van De Snipperling Apeldoorn vertrouwd zijn, verhuizen mee naar dit adres.

18
Harry Kiesbrink, Koen Geertsema, Henk van den Heuvel, Roel van Heeswijk en Frans Evers
Broekhuis: Wie zijn wij?
In 1932 startte Hendrikus Broekhuis in Barneveld met het familiebedrijf Broekhuis. Met de verkoop en het onderhoud van auto’s, zette hij de eerste stap naar Broekhuis zoals wij dat vandaag kennen. Zijn aanpak: ‘Hoge en constante kwaliteit van producten en betrouwbare en correcte benadering van klanten’. Inmiddels zijn wij uitgegroeid tot een onderneming met meer dan 19 automerken en tientallen dealervestigingen verspreid over een groot deel van Nederland, waaronder heel Midden-, Oost- en Noord-Nederland.
Extra automerken bij Broekhuis Apeldoorn
Door de overname van de De Snipperling Apeldoorn bent u voortaan van harte welkom op een ander adres voor de automerken Fiat, Jeep en Alfa Romeo. De werkzaamheden en showroom verhuizen naar de Laan van Malkenschoten 85. Op dit adres is reeds Broekhuis Opel Apeldoorn gevestigd en daar worden de merken Fiat, Jeep en Alfa Romeo aan toegevoegd.
Bij Broekhuis kunt u terecht voor alle zaken rondom mobiliteit. Variërend van het leasen, dan wel aankopen van een nieuwe of gebruikte auto en voor reparatie en onderhoud. Voor Opel, Fiat, Jeep of Alfa Romeo zit u bij Broekhuis in Apeldoorn meer dan goed. Ook als u geen van deze merken rijdt, bent u natuurlijk meer dan welkom bij ons filiaal. De algemene kennis is enorm bij alle werkplaatsen van Broekhuis.



Klantbelo en Broekhuis wil een zeer betrokken onderneming zijn en blijven. Niet alleen in onze ogen, maar juist ook in de ogen van u als klant en van de maatschappij. Dagelijks zetten onze medewerkers zich voor de volle 100% in met als doel ‘alles voor een enthousiaste klant’.



Mobiliteit is mensenwerk Maar wat kenmerkt een Broekhuis medewerker? Mensgericht en oplossingsgericht werken zit in het DNA van onze medewerkers. Om dit zo goed mogelijk uit te dragen, doen wij u vier belo es:
Broekhuis Apeldoorn
Tel. 055 - 538 05 00
19
Kom langs of kijk op broekhuis.nl
Laan van Malkenschoten 85 7333 NP Apeldoorn
Probeer

















1.
























3. Geniet. Heeft u uw keuze gemaakt? U ontvangt zo snel mogelijk uw nieuwe zitmeubel.







vindt ons door heel Nederland:

Set ‘Willeke Alberti’ 2-zits relaxbank 1590,Willeke relaxstoel 1249,Bolsena bijzetfauteuil 990,Setprijs 3829,30% korting op stoel + bank combinatie nu 2680,+ Royaal Velderhof Kerstpakket Boordevol lekkers Gezellig met vrienden en familie Sfeervol tijdens de donkere dagen Een hele avond genieten Mooie mix tussen eten en drinken Profiteer nu van 650,- inruilkorting én ontvang gratis het royale Velderhof Kerstpakket bij een vrijblijvende afspraak. *Kijk op velderhof.nl/algemene-voorwaarden. Op geselecteerde modellen. Nu al v.a. 970,Relaxstoel Endine geprijsd Kijk op www.velderhof.nl of bel 0499 - 729 366 Relaxstoel Serchio 1445,v.a. 795,1945,v.a. 1295,Sta-op stoel Varese Stoel van de maand! Relaxstoel Tirso Nu al v.a. 795,Deze week Apeldoorn Asselsestraat 34 Velp Hoofdstraat 59 Laren Brink 10D Best Koningin Julianaweg 13 NIEUW Breda Slingerweg 87 Beek Aldenhofstraat 78
Haren Rijksstraatweg 205
U
Kom naar de winkel voor het beste advies over goed
Een
Bel
NIEUW 366 www.velderhof.nl
2.
Ervaar. Probeer uw geselecteerde stoelen vrijblijvend bij u thuis of bij de Velderhof winkel in Apeldoorn of Velp.
in 3 stappen uw perfecte stoel vrijblijvend uit in Apeldoorn of Velp.
Ontdek. Kies uw favoriete stoelen uit de uitgebreide Velderhof collectie.
zitten.
goed (zit)advies is maatwerk. Kom naar de Velderhof winkel of maak een vrijblijvende afspraak.
0499 - 729
Buurjongen
In Apeldoorn is onlangs een jongen verongelukt. Op zijn fiets aangereden door een auto vol jongeren, die veel te hard ging. Hij werd twintig jaar. Dit bericht had ik al vol afschuw met mijn gezin gedeeld, maar op straat hoorde ik mensen erover praten. Het was hun buurjongen, begreep ik…
mij geen dwingende kracht meer. Tijdstippen tellen als richtlijnen, maar zeker niet als vastgelegde grenzen.

Het sijpelde ook door in mijn opvoeding. Was mijn puber laat voor een les? Dan moest die zich liever richten op de volgende, maar alsjeblieft niet stressen in het verkeer!
Dit viel mij op Het liefste wil ik dit jaar geen nieuwe jurk kopen
“Iets wat mij opvalt, is dat de donkere dagen nu echt beginnen. Het wordt al vroeg donker en mijn gedachten gaan naar de feestdagen. Met de familie zorgen we altijd voor een gangendiner met verschillende hapjes. Dus ik begin na te denken over wat ik zal maken en toevallig stond ik gisteren





al voor mijn kledingkast. Het liefste wil ik geen nieuwe jurk kopen, want alles wordt al steeds duurder. Ik maak me daar wel zorgen om, ja. Dus ik wil iets dragen dat ik gewoon al heb, maar ik wil toch dat iedereen even denkt: o wauw. Begrijp je wel? Dat is waar ik nu mee bezig ben.” – Maaike
HET VOELDE TE INTIEM

Ook in bredere zin werd het mijn levenshouding. In stress-situaties verlegt mijn focus zich ernaar om éérst het hoofd koel te maken en pas daarna de deadlines te halen – want dat lukt altijd met voldoende rust.



Ik probeerde niet te luisteren, het voelde te intiem. Mijn gedachten katapulteerden bovendien naar mijn kindertijd. Mijn buurjongen is destijds ook omgekomen in het verkeer. Hij werd maar veertien jaar. Kennelijk was hij laat voor school en vanwege de haast koos hij een snellere route die hem op een fietspad langs vrachtwagens leidde. Dit bepaalde zijn lot…

Voor mij was deze gebeurtenis life changing. De klok, bijvoorbeeld, is voor
Nog iets, want het ongeval van mijn buurjongen was een dubbele shock: het gebeurde op mijn verjaardag. Ik werd negen jaar oud. Ik herinner me dat zijn jongere broertje uit de klas werd gehaald en ik herinner me mijn schuldgevoel over mijn jarig-zijn.
De rest van mijn leven gaan mijn gedachten op elke verjaardag even naar Henk, die mijn buurjongen was. Zo zullen de betrokken Apeldoorners ook altijd aan deze jongen blijven denken. Ik wens zijn familie en naasten veel sterkte en kracht.
Is jou ook iets opgevallen? Stuur het in ca. 10 regels naar nanda@stedendriehoek.nl, o.v.v. ‘dit viel mij op’.






Voor de feestdagen maak ik me extra mooi
Saniye, 42 jaar, Apeldoorn: “Ik vind dat je je beter voelt als je je even leuk aankleedt. Dan zit je rechterop en je denkt: Ha, feest! Ik snap het niet als mensen in een fleecetrui aan tafel komen zitten. Ik vind het leuk om een leuk jurkje aan te trekken, met een leuk make-upje. Dat het net even een themaatje van kerst is, dat het in dat stijltje past. Het hoeft niet allemaal met glitter, maar wel alsof je naar een leuk feest gaat, ook al zit je aan tafel.”



Regina, 40 jaar, Deventer: “Ik doe het altijd wel, ik vind het fijn om er mooi uit te zien. Mooie kleren en een make-upje op en dergelijke. Met de feestdagen doe ik wel extra mijn best. Of ik speciale kerstkleding heb? Er mag wel een glittertje bij, zeg maar. Ik draag wat meer glitter & glamour. Normaal gesproken draag ik geen hoge hakken, maar dat wil ik ook nog wel aantrekken. We vinden het hier allemaal wel leuk om mooie kleren te dragen, dus het hele gezin kleedt zich mooi.”

Ganna, 45 jaar, Apeldoorn: “Ik maak mij nooit mooi voor een ander. Dat doe ik altijd voor mezelf. En ja, ik vind het leuk om daar mijn best voor te doen. Dat is met kerst niet minder. Mijn zoon draagt vaker zijn overhemd, maar nu komt de strik er extra bij. Zelf hou ik van lekker een gouden jurk aan met hoge palen eronder. Ik heb meerdere gouden jurken. Als ik eerlijk ben vind ik feestdagen meestal erg leuk. Niets houdt mij tegen om mij mooi aan te kleden.”




21 COLUMN NANDA ROEP





















De mooiste merken in de cupmaten A t/m L 20% korting op alle MEY artikelen! MEYacti e Bij besteding vanaf € 50,aan MEY producten maak je kans op een GRATIS lingerie set van MEY! Zwolseweg 221 Apeldoorn Tel. 055-2002037 bodywearsuperstore.nl Acties alleen geldig in de winkel. Vraag in de winkel naar onze actievoorwaarden. dames enheren
Voorbereiding op tweede seizoenshelft van start
De selectie van Go Ahead Eagles is vorige week begonnen aan de voorbereiding op de tweede seizoenshelft van voetbaljaar gang 2022/2023. Op dit moment worden de laatste puntjes op de i gezet met betrekking tot het voorbereidingsschema, dat naast trainingen ook uit een aantal besloten oefenwed strijden zal bestaan. Een complex traject, waarbij het inpassen en vastleggen van de juiste oefentegenstanders regelmatig pas in een laat stadium definitief gemaakt kan worden.
“Een aantal oorzaken ligt ten grondslag aan het beslo ten karakter van de meeste oefenwedstrijden die we in december spelen”, zegt alge meen directeur Jan Willem van Dop. “De belangrijk ste reden is het verkrijgen van een vergunning voor het spelen van wedstrijden mét publiek op het sport complex van een amateur vereniging. Een dergelijke vergunning dient meerde re weken van tevoren aan gevraagd te worden en die tijd hebben we simpelweg niet voor het benaderen en vastleggen van tegenstan ders en amateurcomplexen en het definitief invullen
van het oefenprogramma voor deze – ongebruikelij ke – voorbereidingsperiode in december. Voor het spelen van een oefenwedstrijd zón der publiek geldt daarnaast in veel gevallen als aanvul lende veiligheidsvoorwaarde dat – onder meer op ver zoek van de lokale autoritei ten, onze ketenpartners en/ of onze tegenstander – de locatie en het aanvangstijd stip van de besloten oefen wedstrijd pas ná afloop van het duel bekend gemaakt mogen worden. Gevolg is dat we voorafgaand en tij dens oefenduels minimale wedstrijdinformatie mogen en kunnen verstrekken richting onze supporters, maar pas na afloop naar
buiten zullen treden middels een wedstrijdverslag op onze website en socials.”

In theorie zou De Adelaarshorst voor het spe len van oefenwedstrijden mét publiek een alternatief kun nen zijn. “Hiervoor beschik ken we over een doorlopen de vergunning”, geeft Van Dop aan. “Aan deze door lopende vergunning zit ech ter wel een maximum aantal wedstrijden dat we per sei zoen mét publiek in het sta dion mogen spelen, aange zien elke wedstrijd met toe schouwers als een evenement wordt gezien. Als we zouden besluiten om in december een



oefenwedstrijd mét publiek in De Adelaarshorst te spe len, dan zou dat dus kunnen betekenen dat we later in het seizoen in de problemen kunnen komen, mochten er onverhoopt extra thuiswed strijden in het bekertoernooi en/of de play-offs bij ons op de wedstrijdkalender komen. Al met al hadden we uiter aard zelf natuurlijk ook liever
gezien dat alle oefenwed strijden voor publiek toegan kelijk zouden zijn, maar we hopen ook dat onze sup porters begrip hebben voor alle afwegingen die we als club dienen te maken om ons met onze eerste selec tie zo optimaal mogelijk voor te kunnen bereiden op de tweede seizoenshelft in de Eredivisie.”


Speeldata en -tijden tweede
seizoenshelft bekend
De KNVB heeft het definitieve speelprogramma voor de tweede seizoenshelft van seizoen 2022/2023 bekendge maakt. Go Ahead Eagles zal de competitie op zaterdag 7 januari hervatten met een uitwedstrijd tegen Fortuna Sittard (aftrap 20.00 uur).
Voor Go Ahead Eagles staan er nog twintig wedstrijden op de planning, waarvan twaalf op zondag, vijf op zaterdag, twee op vrijdag en één op woensdag. Het volledige programma is hieronder te vinden:
Fortuna Sittard-Go Ahead Eagles (zaterdag 7 januari, 20.00 uur)
Go Ahead Eagles-FC Utrecht (zondag 15 januari, 14.30 uur)
RKC Waalwijk-Go Ahead Eagles (zaterdag 21 januari, 21.00 uur)
Go Ahead Eagles-AZ (woensdag 25 jan., 18.45 uur)




PSV-Go Ahead Eagles (zaterdag 28 januari, 16.30 uur)
Go Ahead Eagles-NEC (zondag 5 februari, 14.30 uur)
Sparta Rotterdam-Go Ahead Eagles (zondag 12 februari, 12.15 uur)
Go Ahead Eagles-FC Twente (zondag 19 februari, 14.30 uur)
FC Emmen-Go Ahead Eagles (zondag 26 februari, 14.30 uur)
SC Cambuur-Go Ahead Eagles (zondag 5 maart, 20.00 uur)


Go Ahead Eagles-RKC Waalwijk (vrijdag 10 maart, 20.00 uur)
FC Utrecht-Go Ahead Eagles (zaterdag 18 maart, 16.30 uur)
Go Ahead Eagles-Ajax (zondag 2 april, 12.15 uur)
Vitesse-Go Ahead Eagles (zaterdag 8 april, 18.45 uur)
Excelsior-Go Ahead Eagles (vrijdag 14 april, 20.00 uur)
Go Ahead Eagles-Fortuna Sittard (zondag 23 april, 14.30 uur)

Go Ahead Eagles-FC Groningen (zondag 7 mei, 14.30 uur)
Feyenoord-Go Ahead Eagles (zondag 14 mei, 16.45 uur)
Go Ahead Eagles-FC Volendam (zondag 21 mei, 14.30 uur)
sc Heerenveen-Go Ahead Eagles (zondag 28 mei, 14.30 uur)
23
Go Ahead Eagles ZA. 17 DECEMBER Boode Bathmen 21 jan - 25 feb www.swingnight.nl Kom langs in onze showroom! Staverdenseweg 17, 8075 AN Elspeet Heeft u vragen? Bel 085 - 40 16 594 of stuur ons een bericht via maxwelzijnswinkel.nl Vraag uw adviseur naar de voorwaarden. Actie alleen geldig in Elspeet. Geldig t/m 31-12-2022. Niet in combinatie met andere acties. Onder voorbehoud van druk- en zetfouten. Showroom uitverkoop Profiteer de hele maand december van spectaculaire eindejaarsdeals in onze showroom in Elspeet Bel 085 - 40 16 594 voor persoonlijk advies op maat Bedden tot 80% korting Kussens tot 35% korting Stoelen tot 80% korting Banken tot 45% korting Deze vacatures zijn is echt wat voor jou als je: Bekijk de vacatures op werkenvoorapeldoorn.nl en solliciteer! KOM JIJ ONS TEAM VERSTERKEN? Vakbekwaam Medewerker Groen en Medewerker groen/machinist VACATURES (M/V/X) Apeldoorn mooi en klimaatbestendig wil
leuk team
baan
om zo
biodiversiteit
op jouw vakgebied;
maken; in een
wil werken; een afwisselende
in het groen wil; met jouw werk een bijdrage wil leveren aan ecologisch beheer
de
in Apeldoorn te vergroten. wil blijven ontwikkelen













20% korting Decoratieve buitenverlichting en Fairybells Bijv. LED polestar hangend 45 cm 19.95 / 15.96 Fairybell 300 cm. 480 LED. Incl mast. 239.- / 191.20 Zet deze winter de gezelligheid aan in je tuin. De mooiste verlichting koop je bij Welkoop. Laan van de Dierenriem 54|Laan van Spitsbergen 89| Apeldoorn
APELDOORN - Middelink
Wonen heeft vorige week de deuren geopend van het nieuwe onderkomen aan de Vlijtseweg 180. In de schit terende en overzichtelijk ingerichte winkel voelt Frank Buijs, sinds 2011 eigenaar, zich zichtbaar als een vis in het water. “Wat een fijne plek. De mensen komen zo vanuit de supermarkt even hier kijken in mijn gezellige winkel. Een nieuwe uitda ging, die ik met veel plezier aanga.”

In het oude pand van Middelink Wonen aan de Asselsestraat 88, op de hoek met de Wilhelmina Druckerstraat, had Frank twee woonlagen, op de nieuwe locatie één. Maar qua winkelruimte - plusminus 700 m2 - is hij er niet op ach teruit gegaan. “Sterker, alles
gelijkvloers is voor veel klan ten beter. De trap op was toch vaak een drempel.” Liefst 103 jaar was Middelink gevestigd aan de Asselsestraat. Jaren geleden is de winkel opge splitst in Middelink Wonen, Middelink Koken & Tafelen en Middelink Slaapmode.
Laatstgenoemde zaak blijft ook aan de Asselsestraat, Koken & Tafelen sluit eind dit jaar definitief.

Frank speelde al langer met het idee voor een nieuwe loca tie. “Middelink is een begrip in Apeldoorn en omgeving, maar de oude plek was niet
heilig. Hier kan ik de meu belen, woonaccessoires, ver lichting, (pvc)vloeren en bin nenzonwering een fijne plaats geven en kunnen de klan ten in alle rust wooninspira tie opdoen.” Omdat hij zich op de bovenverdieping heeft gevestigd, wijst hij shoppend
Apeldoorn er graag op hoe ze zijn winkel het eenvou digst kunnen bereiken. “Bij de DekaMarkt neemt u de rol trap naar boven. Komt u met de auto, dan rijdt u het par keerdek op en staat u met een voor mijn deur, met gratis parkeren!”
Levensloopbestendig wonen in een Knarrenhof
APELDOORN - Een groot deel van de Apeldoornse bevolking is 60 jaar of ouder. Dat aantal neemt in de komende jaren nog verder toe. “De roep om goede, passende, levensloop bestendige woningen wordt steeds groter”, zegt Monique Nijhof daarom.
“Al deze (toekomstige) 60-plussers wonen in grote eengezinshuizen. Zij willen best verhuizen. Maar waar naartoe? Hun huizen wonen plezierig, bieden voldoende vrijheid en kennen privacy.
Alleen, het is te groot en kent vaak geen slaap- en badka mer op de begane grond.”

Er is een oplossing hiervoor,
aldus Nijhof. “Voor zowel de langere termijn alsook voor de situatie van nu. Voor nu geldt dat de doorstroming op gang moet komen, waar door ook starters en jonge gezinnen weer een goede en passende plek krijgen om te wonen. Voor later geldt dat de doorstroming veel min der nodig zal zijn, omdat

woningen en woonomgeving zijn voorbereid op ‘levens loopbestendig’ wonen. De oplossing is te vinden in het bouwen van veel meer levensloopbestendige wonin gen. En aanvullend daarbij dat deze woningen in een opstelling gebouwd worden, zodat bijvoorbeeld de een zaamheid wordt ondervan gen en aandacht voor elkaar vanzelfsprekend is.”
Juist hiervoor maakt Stichting Knarrenhof zich sterk, knikt Nijhof. “Knarrenhof staat
voor woonplekken waar mensen zelf hun - eigen en gemeenschappelijke - woon ruimte bepalen. Waar ze onderling afspreken elkaar te helpen als het kan en nodig is. En vooral om het met elkaar goed te hebben. Woningen die mogelijkhe den bieden (in de toekomst) voor als er meer zorg nodig is. Een plek die duurzaam is en toegankelijk voor men sen met een krappere beurs. Een plek waar veel autono mie, samen leven én priva cy samen gaan. Eigenlijk niets
nieuws onder de zon. We kennen immers de prachtige ‘Begijnhofjes’ die nog steeds in grote steden zijn te vin den. Saamhorigheid in een omgeving waar naar elkaar wordt omgekeken zonder dat het eigene in wonen en leven verloren gaat. Noaberschap is een mooie Twentse duiding die niet alleen voor dat deel van het land van toepassing hoeft te zijn, toch?”
Diverse gemeenten hebben dit initiatief omarmd. Op diverse plekken in Nederland


Nieuw in het uitgebreide assortiment van Middelink Wonen zijn onder meer de robuuste, stijlvolle tafels van het merk Bruuts. Daarnaast heeft Frank een select assor timent uit Koken & Tafelen overgenomen, een teken dat het ‘Middelink-DNA’ ondanks de opsplitsing van de winkels nog altijd sterk is. Frank kijkt tevreden rond in zijn nieuwe zaak: “Ik ben er trots op dat ik dit, met alle mensen om me heen, in zo’n korte tijd heb gere aliseerd. Waarbij ik in elk geval wel even Bisseling Installatietechniek wil noe men, want die hebben hier enorm puik werk geleverd.”








Voor meer informatie, tele foon 055-5785725, e-mail info@middelink-wonen.nl en website middelink-wonen.nl

is een dergelijke Knarrenhof gerealiseerd of in aan bouw. Nijhof: “Apeldoorn kan niet achterblijven, want ook in Apeldoorn is de roep om een dergelijke woon vorm groot.” Een enthousi aste initiatiefgroep is inmid dels gestart in Apeldoorn. Veel inwoners hebben zich inmiddels ingeschreven bij de Stichting Knarrenhof. Wie ook wil meehelpen, kan zich aanmelden via de website www.knarrenhof.nl. Daar is veel meer informatie te vinden.


- ADVERTORIAL25
Middelink Wonen is open aan de Vlijtseweg! Visschotel Royal Luxe Zalmsalade Vis Feestje Haring Feestje Want vis is Feest ! per schaal € 27,50 Tonijnfilet - Zalmfilet met huid - Garnalen scampi Scholfilet - Kabeljauwfilet - zeeduivelfilet Passende marinade Laan van Orden 199, 7312 KH Apeldoorn 055 - 356 08 04 info@devischmarkt.nl | www.devischmarkt.nl
reserveren. Vers bereide zalmsalade - Palingfilet gerookte zalmfilet -
garnalen Heet gerookte zalm - Heet gerookte haring Gerookte makreelfilet - Zeewiersalade Wraps met zalm
Sausjes
Haring Vers bereide zalmsalade - Gerookte palingfilet Gerookte zalmfilet - Hollandse garnalen Heet gerookte zalm - Koud gerookte haringfilet
Wraps - Tonijn Tataki - Sesamsaus - Wakamesalade Palingfilet - Zalmfilet - Heetgerookte
Gerookte
Brado
Een feestelijke visschotel met: Palingfilet - Gebakken kibbeling Gerookte zalmfilet - Heetgerookte zalmfilet Gerookte makreelfilet - Haring Brado - Jumbo garnalen Voor de echte haringliefhebber met: 12 Haringen - Uitjes - Zuur S = 2 tot 3 pers. € 40,00 M = 4 tot 6 pers. € 55,00 L = 6 tot 8 pers. € 75,00 S = 2 tot 3 pers. € 30,00 M = 4 tot 6 pers. € 45,00 L = 6 tot 8 pers. € 65,00 Visschotel De Luxe Gourmetschotel S = 2 tot 3 pers. € 40,00 M = 4 tot 6 pers. € 60,00 L = 6 tot 8 pers. € 80,00 S = 2 tot 3 pers. € 30,00 M = 4 tot 6 pers. € 45,00 L = 6 tot 8 pers. € 65,00 S = 2 tot 3 pers. € 30,00 M = 4 tot 6 pers. € 45,00 L = 6 tot 8 pers. € 65,00
Graag vooraf
Hollandse
-
-
Gerookte makreelfilet
zalm
makreelfilet - Haring - Hollandse garnalen
- Cocktailsaus
















































































































MEUBEL EVENT 8+9+10+11 DECEMBER GORSSEL + ZUTPHEN Footstools 50x50cm Deze week kopen, volgende week zitten! Afmeting: 274cm x 254cm 2-zits - 140cm breed 2,5-zits - 208cm breed 180cm breed in vele kleuren Heel veel meubels uit voorraad leverbaar. Wilt u toch iets anders, dan maken wij dit graag speciaal voor u! Woonkamer nog niet klaar? Dan slaan we het graag voor u op! Stof Mystic is oersterk, slijtvast, vlek- en waterafstotend en verkrijgbaar in vele kleuren Spittaalstraat 6-8 te Zutphen Spittaalstraat 6-8 te Zutphen Hoofdstraat 47e te Gorssel Hoofdstraat 47e te Gorssel John Bardale Meubelevents vinden plaats: John Bardale Meubelevents vinden plaats: Openingstijden: Openingstijden: Di + woe: 11-17 u | Do + vrij + zat: Di + woe: 11-17 u | Do + vrij + zat: 10-17u 10-17u Zondag: Zondag: 12-16u 12-16u www.johnbardale.com Preston 24 Preston 24 Gobi 02 Gobi 02 Tevens interessante Tevens interessante kleding aanbiedingen kleding aanbiedingen voor dames & heren voor dames & heren Moon U1104/FA78
BAK VAN DE WEEK
Een man wordt aangehouden bij een politiecontrole. Vraagt de agent: “Wilt u meewerken aan een alcoholcontrole?” De man knikt: “Natuurlijk! Geef me maar zo’n jasje en zeg maar wat ik moet doen.”
De winnaar van deze week is Jessey Strong uit Apeldoorn die van de Stedendriehoek vijf euro ontvangt.
HUWELIJK & KENNISMAKING
Weduwe zoekt een lieve weduwnaar voor een latrelatie, leeftijd tussen de 62 tot 68 jaar.
Brief onder nummer: Uitgeverij Stedendriehoek, Asselsestraat 140, 7311 ET Apeldoorn.
MOTOREN
Motorliefhebber zoekt motorfiets tot 1980. BMW, Honda, etc. Ook lang stilstaande. Tel.: 06-22571321.
STOFFEREN
STOFFEERDERIJ JOHAN
Jarenlange ervaring met het stofferen van al uw MEUBELEN, opvullen van KUSSEN en inkleuren van leer, biezen en rieten matten. BEL: 06-22926757.
MISF(R)ITS
‘Dus hij komt nooit meer terug? Ook niet met Kerstmis, ofzo?’ De kleine pony heeft natte oogjes. De wind is waterkoud, dat was het volgens hem. We zitten met zijn allen in de kleine wei. De modder is gehard van de kou, onze zielen zijn dat niet. ‘Nee, we gaan hem nooit meer zien’, opper ik dapper. Ik vind tranen fijn, het zegt dat ik leef en voel.

De oude kat is stilletjes, dat is hij eigenlijk altijd. Stil maar aanwezig, dat is op zich ook knap. Ik pluk wat aan de pony. De buren hebben een vuurkorf aan, het loopt al tegen schemer. Het bonte boeltje zit in een kring, er is één belangrijk iemand die mist. Dat is al een
paar dagen zo, maar hoop doet leven. De kleine pony zocht onder de struikjes, de rooie kater ging de daken af. Je weet het niet, in deze tijden, misschien nam het grote paard een cursus af van Sint.
De zwarte bleef stokstijf bij de achterdeur, daar had hij het meeste overzicht. De schapen liepen rondjes, ze wisten zelf ook niet waarom. De bruine koe bleef bij zijn stal, mocht hij thuiskomen dan was hij niet alleen.

Na dagen zoeken bleef het grote paard weg. Dus moest er vergaderd worden, vond
de rooie kater. ‘We kunnen de uil nog vragen,’ begon één van de nieuwe schapen, ‘die ken ik nog van waar ik eerder woonde.’
De dieren knikken en kijken me hoopvol aan. ‘Hij komt niet meer terug, lieve jongens. Hij is niet meer bij ons. Tenminste, niet in zijn grote lijf. Wel in heel veel andere dingen.’
Het wordt stil in de kring. De egel fronst, de pony zegt niks. ‘Hoe weten we dan,’ begint de zwarte koe, lief maar niet snugger, ‘wanneer hij er is,
VVV 25 JAAR VVV
KRINGLOOP RE-SELL
Voor overtollig huisraad en inboedels ‘tegen betaling’. Wij verzorgen ook het correct leegruimen, schoonmaken en opleveren van uw woning of bedrijf.
Kringloop Re-Sell Coenensparkstraat 36, 7202 AN ZUTPHEN Tel.: 06-12354175
als zijn grote lijf er niet is?’ Goeie vraag vond de kring en alle kraaloogjes schieten mijn kant op.
‘Je moet hem goed zoeken. In kleine dingen. Een windvlaag, een geluidje.’
De kleine pony begint te grinnehinniken. ‘Weet je nog hoe hij kon schreeuwen? Als er iets anders dan anders was?’
De rest van de kring lacht mee. Behalve de rooie kater, die is opvallend stil. Het schaap slaat een arm om hem heen. ‘We komen er wel doorheen, als we samen blijven.’
De kring schuifelt dichter bij elkaar. In de verte klinkt een hard, hoog geluid. Alle natte oogjes lichten op. Dáár is hij.
RADIO / TV / MUZIEK
Rock & Roll trio in oprichting zoekt ZANGER/GITARIST. Van Elvis Presley tot Glamrock, Grease, New Wave tot Blues Brothers! Een R &R Party! Contact: Jelle Veltman, tel.: 06-37198550 of email: veltman60@gmail.com.

TUINEN
VLOOIENMARKTEN
Zwolse Vlooienmarkt Zwolle IJsselhallen. Zondag 11 dec: 10-16.30 u. Volgeboekt! Info: www.vitalismarkten.nl
SCHILDERWERK
SCHILDERS VRAGEN SCHILDERWERK buiten- en binnenschilderwerk.
Kwaliteit schilderwerk tegen de laagste prijs Garantie op de werkzaamheden Vrijblijvende Prijsopgave Kleur advies Tel.: 06-26641752.
DIVERSEN
Gevraagd: oud ijzer, accu’s, metalen en witgoed. Wij komen het bij u halen. Eventueel tegen kleine vergoeding. Tel.: 06-14101933.
ONGEDIERTE
Last van mollen?
Laat ze vangen! E.L. de Weerd Tel.: 06-13456651.
HUISHOUDELIJK PERSONEEL
Gevraagd huishoudelijke hulp voor de woensdag of donderdagmiddag. Reactie via email: info@valkman.net
GROTE VLOOIENMARKT DOESBURG
Zondag 18 december SPORTHAL
BEUMERSKAMP, Breedestr. 39, 09-16 uur. Inf. kr.hr. 06-39108152 animo-vlooienmarkten.nl
VLOOIENMARKTEN
Bomvolle tweedehands winkel in Klarenbeek is zondag 11 december open van 11.00 tot 16.00 uur Molenweg 4, met veel kerst

Het bestraten van tuin, terras, oprit, terrein etc. en tuinaanleg, eventueel ook levering van alle materialen. Sinds 1966. Klomp, Tel.: 06-54973731.
VACATURES
Wie wil er voor zorgen dat onze BSO kinderen in een schone ruimte kunnen spelen? Wij zoeken een schoonmaker voor een aantal uren per week in de ochtend.
Interesse? Bel of mail Annemiek Geltink vestigingsmanager Bixo ZVV Tel.: 06-46 958 232 of mail: vmapeldoorn@bixo.nl.



Kunststof kozijnen
Voor renovatie, verbouw en serres. Ook plaatsen en afwerken.
Veluwse Kozijn Techniek De Brink 2A, Lieren Tel. 06 - 51 290 292 info@veluwsekozijntechniek.nl
COLOFON
Postbus 638, 7300 AP Apeldoorn Kantoor, redactie en administratie: Asselsestraat 140, 7311 ET Apeldoorn. Tel. 055 - 5219878
verkoop@stedendriehoek.nl redactie@stedendriehoek.nl www.stedendriehoek.nl Klachten bezorging: 055 - 303 4901 klachten@stedendriehoek.nl Volg ons ook op:
M N S V P
Sluitingstijd advertenties: maandagmorgen 12.00 uur Redactie: vrijdag 17.00 uur voor de week van verschijning Advertentieverkoop: tijdens kantooruren 09.00-17.00 uur.
Acquisitie: Jacqueline Boekema, John Ruisch, Sacha van Beers, John Herbrink Hoofdredactie: Marc Looijen Vormgeving: André Mos, Jack Willemsen
Administratie: Suzanne Boekema-van Buijsen Opgave rubrieksadvertenties (3-hoekjes) Apeldoorn: Kantoor Asselsestraat 140 of via: www.stedendriehoek.nl Uitgave van Uitgeverij Stedendriehoek B.V.
Directie: J. Boekema, F. Boekema Oprichter: J.P.S. Boekema
Rodi Rotatiedruk werkt milieuvriendelijk en verantwoord. Waterless Printing, ISO 14001 Grafimedia en KVGO. Dit krantenproduct is geproduceerd door Rodi Rotatiedruk onder gecontroleerde omstandigheden conform ISO 14001 Grafimedia getoetst door de SCGM, Certificaatnummer SCGM-MZ:2011.01.02
Tel.: 06-29819997 of 06-20653798.

Niets uit deze uitgave mag overgenomen worden, zonder toestemming van de uitgever. In verband met de eisen die recent zijn gesteld door de General Data Protection Regulation (GDPR), willen wij u wijzen op onze privacyverklaring die u kunt vinden op de site: www.stedendriehoek.nl/privacybeleidvan-uitgeverij-stedendriehoek. Bij ingezonden persberichten en foto’s wordt verwacht dat rekening is gehouden met ons privacybeleid en de foto’s rechtenvrij zijn.
WEEKENDDIENSTEN
APELDOORN
Huisartsen: Spoedgevallen 0900-6009000.

Apotheken: Gelre Lukas. Spoedrecept. ma.-vrij. 17.30-24.00 za./zo./ feestdagen 08.00-24.00. Na 24.00 uur, telefoon 0555811840.
Tandartsen: weekend tel. 085-0189466.
Dierenartsen: Bel uw eigen dierenarts Medifoon Apeldoorn: weekend 0900-55.555.555 (100 cpm)

DEVENTER
Apotheken: Apotheek Salland, 24 u. centrale hal Deventer Ziekenhuis, Nico Bolkesteinlaan 75, telefoon 0570-536505.

Huisartsen: voor spoed telefoon 0570-501777.
Tandartsen: 10 en 11 december, De Deventer Tandartspraktijk, Diepenveenseweg 21, telefoon 0570-244161.
Dierenartsenpraktijk: Keizerslanden, Graaf Florisstr. 1b, tel. 0570-622288.
TWELLO: Dierenkliniek Twello B.V Molenstraat 49, Twello, telefoon: 0571-272624
GROOT COLMSCHATE Huisartsen: Centraal telefoon: 0570-501777.
Regio Dierenambulance 0900-9991999 (45 eurocent).

VOORST-KLARENBEEK
Dierenartsen: De Driehoek, telefoon 055-3012255.
ZUTPHEN: Huisartsenpost Zutphen: telefoon 0900-2009000, werkdagen 17.00-08.00 uur, weekend 24 uur bereikbaar.
Apotheken: Dienstapotheek Gelre Apotheek Zutphen, Den Elterweg 77, tel. 0575-744800.
Tandartsenkring Zutphen e.o. Spoedgevallen weekend telefoon 0575-512288.
Dierenartsen: De Graafschap Dierenartsen, 24-uurs dienstverlening, telefoon 0575-587880.
WARNSVELD Homeopathie praktijk: zaterdag 10.00-12.00 uur en op afspraak via tel. 0575-573103.
Word nu lid op natuurmonumenten.nl en ontvang 4 x per jaar het magazine Puur Natuur WE KUNNEN NIET ZONDER NATUUR 27
ADVERTEREN? bel voor meer informatie: tel.: 055-5219878
START KERSTPERIODE Na deze maandag is Sint is afgevinkt dus de lampjes kunnen in de bomen of aan het balkon. Tijd om een mooie boom te scoren, het huis te versieren en nog drie weken lang te broeden op het kerstmenu. Kortom, het is druk-drukdruk tijdens de donkere dagen voor Kerst. Gelukkig kan er ook online, overal 24/7 heel wat geregeld worden. ZOEK DE 10 VERSCHILLEN ADVERTEREN? BEL 055-5219878 of mail naar verkoop@stedendriehoek.nl via website https://www.stedendriehoekadverteren.nl/driehoekje jes Naam: ____________________________________________________________ Straat + huisnr.: ____________________________________________________ Postcode: _________________________________________________________ Plaats: ____________________________________________________________ Stuur uw oplossing voor 13 december 2022 naar Uitgeverij Stedendriehoek, Asselsestraat 140, 7311 ET APELDOORN of per e-mail naar puzzel@stedendriehoek.nl Maak kans op 2 entree-kaarten Wintercircus Apeldoorn 916 97 1927 84627 38 71542 4837 84 173 647 659 132 593 328675 482 675 943 914 HOBBY’S Creatieve Workshops speksteen + boetseren en Cursus boetseren met klei + was in Gigant. Info + aanmelden: www.barbsgallery.com CONTACTEN
Erectiemiddelen bestellen?
en
NIEUW:
Anita bellen Afhalen
bezorgen.
POSTZEGELS, MUNTEN, ZILVER & GOUD; GRATIS TAXEREN VOOR VERKOOP BIJ T.G. Gibsonstraat 17 - Deventer - 0570 831255 - www.hetinkoopkantoor.nl
ZA. 17 DECEMBER Boode Bathmen 21 jan - 25 feb www.swingnight.nl
Tuinen De Roode Hoeve Middendijk 14 Nijbroek. www.tuinenderoodehoeve.nl SFEERDAGEN ZA 10 ÈN ZO 11 DEC. 10.00 – 17.00 UUR € 6 p.p. incl ko e met gebak!
Puzzelplezier en prachtige prijzen
STEDENDRIEHOEK -
Elk jaar doen er meer deelnemers aan de puzzel mee Logisch, want niet alleen is het heerlijk om te puz zelen, vooral met dit koude decem berweer, maar ook is de puzzel makkelijk in te vullen Iedereen kan dus meedoen En natuurlijk zijn er ook dit jaar weer prachtige prijzen te winnen, beschikbaar gesteld door ondernemers in de regio Misschien bent u straks wel net zo blij als Sylvia Spijkerman uit Diepenveen, die bij Wooonze in Deventer een meubel cheque van 200 euro kreeg uitge reikt Ook voor deze puzzel ligt bij Wooonze dezelfde prijs klaar
Spelregels
De spelregels zijn heel simpel Je bekijkt de speciale puzzelpagina’s
In het invulschema staan - genummerd van 1 tot en met 126 - (stukjes van) zinnen die voorko men in de advertenties op de puz zelpagina’s Aan jou de taak om bij iedere zin de bedrijfsnaam van de adverteerder te vinden Let op: som mige adverteerders hebben meer dere vakjes!!! Zet de oplossingen op de stippellijnen van het invul schema
Een spectaculair prijzenpakket Ook dit jaar zijn er tal van onder nemingen die de winnaars van de puzzels verwennen met een mooie prijs De prachtige prijzen maken het zeker de moeite waard om de puzzel te maken en de oplos sing in te sturen Zo stelt Dirk Blok
een fijne kinderfiets beschikbaar, Electro World Hamer een televi sie en ligt bij RTV Stegeman een Tefal stoomstrijksysteem klaar Tara SkinCare schenkt een gezondheids pakket ter waarde van € 100,En de prijzenparade gaat verder… Marcel’s Kaas (Kaas van het Loo) maakt een winnaar blij met 1 kilo kaas Cinemajestic biedt bioscoop kaarten aan Margriet Bloemen komt met een waardebon van € 25,-, De Gezonde Zaak met 5x een waardebon van € 15,- en De Vischmarkt met 2x een waardebon van € 15,- Sanisale geeft een acces soire-setje weg Zijn we er al? Welnee! Wat te denken van 2x2 vrijkaarten voor het Speelgoedmuseum in Deventer,
2x2 vrijkaarten voor VUE Deventer, een geurkaars True Grace no.5 van Pillows Luxury Boutiquehotel aan de IJssel in Deventer, 2x2 vrij kaarten van het Geert Groote Huis in Deventer, een dinerbon van 25 euro van Martins Döner in Diepenveen, 2x2 vrijkaarten voor Amusementspark Tivoli in Berg en Dal, 5x2 vrijkaarten voor het Oude Ambachten & Speelgoedmuseum in Terschuur en 2x2 vrijkaarten voor een film bij MIMIK in Deventer? Dros Schoonmaakdiensten biedt een JBL Go 3 bluetooth speaker ter waarde van € 40,- aan En ook www.event-store.nl gaat een winnaar heel blij maken Zij bie den een waardebon van 100 euro waarmee je zelf een keuze kunt maken uit de vele cadeaus op de website Een diner voor twee, ballon varen, slipcursus, parachutesprong, zweefvliegen, quadrijden of ritje in een Ferrari Maar ook pretparken,
musea zoals het Rijksmuseum of het Van Gogh museum en dierentuinen zitten in het aanbod
Insturen oplossing Uren puzzelplezier en zoveel mooie prijzen te winnen… laat de decem bermaand maar lekker fris worden! Is de puzzel compleet? Stuur de oplossing dan naar Nieuwsblad Stedendriehoek Dit kan door een mail te sturen naar puzzel@ stedendriehoek nl, of door de oplos sing op te sturen naar Postbus 638, 7300 AP in Apeldoorn (zet in de linkerbovenhoek Decemberpuzzel 2022) Afgeven aan de balie aan de Asselsestraat mag ook Vergeet niet je naam, adres, woonplaats en telefoonnummer te vermelden De prijswinnaars ontvangen persoonlijk bericht en worden bekend gemaakt in Nieuwsblad Stedendriehoek De oplossing moet uiterlijk woensdag 11 januari 2023 in ons bezit zijn
1
Administratie goed voor elkaar? 2 Merino wol 3 ( junior ) Intercedent 4 € 1399,-5 € 1499,-6 € 699,-7 055-2032622 8 0570-546464 9

1e kerstdag en Nieuwjaarsdag gesloten! 10 350 auto’s op voorraad 11 7442 CT Nijverdal 12
Al 62 jaar een begrip in Apeldoorn 13
Allround monteur hydrauliek 14 Apeldoorn diVERS nl 15 Arbeidsrecht Advocatuur 16 Betrouwbaar Betrokken 17 Beweegt mensen 18
Biedt professionele flexibele kinderopvang 19 Blijf jong en fit 20 Blijf mobiel 21
Boerderijwinkel en melktap 22 Brocante & curiosa 23 Broddaz Beach 24 Cadeaubon 25 Colliers ( op elke lengte leverbaar ) 26 Dagbesteding 27
De airconditioning specialist 28
De betere christelijke boekhandel 29 De kunst van mooi wonen 30 De Meente 7 31
De mooiste stoffenzaak van Nederland 32 De specialist in Zonnepanelen 33
De stratenmaker 34
De Tuinexpert 35
Dorpsstraat 13A 36 Dreef 140 D 37
Een gratis mandje 38
Een liefdevol afscheid kan helpen… 39 Een ontwikkeling van 40 Een warm welkom 41
Eenvoudig te reinigen 42
Engineer/calculator HVAC 43
Familie- en erfrechtadvocaat 44
Floris Hovers Kerststal 45 Flowers & more 46
Ga mee op ontdekkingsreis 47
Geen ruit is te klein of te groot 48
Gratis advies op maat bij u op locatie 49
Gratis bezorging met eigen bezorgers 50
Gratis vervangende auto 51
Hardlopen begint bij 52
Heerlijk ontspannen Zwevend en dromerig,
Hyundai 54 Ik sta u bij
In uw woning, genieten van de warmte 56
Industrieterrein Kloosterlanden 2 57 Infocentrum Noorderhaven 58
Interieurverzorgers 59
Jouw huis, jouw tuin, jouw stijl 60
Kerstmarkt 61
Keuken & apparatuuroutlet 62
Kijk ook eens op biljartwinkel nl 63
Kledingreparatie- en verstelatelier
64
Klokken en antiek 65 Kom kijken en vergelijken 66 Kom zwemmen bij 67 Koninginnelaan 97 68
Koningstraat 3 69 Lampen nodig? 70
Lekker vers en gezond 71 Liever theater cadeau 72
Meer dan 75 soorten plukbloemen 73 Met meer dan 300 gedenkstenen 74 Monteur brandbestrijdingstechniek 75 Monteur brandstoftechniek 76
Mooi voor elkaar 77 Motieven 78
Neem gerust contact op 79 Nieuw: De Turkse Nordmann 80 NOBCO 81
Oerdijk 19 82
Omdat voeten ook gevoel hebben 83 Ongeacht waar u verzekerd bent 84 Ontbijt - Lunch 85
Oplagruimte nodig? 86 Our energy Your power 87
Passend wijnadvies voor bij uw dinergerechten 88 Paulien 89
Pony en paardrijles 90
Projectleider elektrotechniek 91 Retailtechniek 92
Rijwielspecialist 93
Sanitair-tegeloutlet 94 Scheltens & Abbenes 95 Schubertlaan 20 96 Schuttersweg 88 97
Servicemonteur elektrotechniek 98 Specialist in arbeidsrecht 99 Sterk in elk merk 100
Stok achter de deur nodig? 101 Stop! Met snurken 102
Storingscoordinator 103
Tegen inlevering van deze advertentie 104 Tijdelijk gratis berzorging! 105
To-go loket 106
Uw adres voor verlovings- en trouwringen 107 Van bijzonder tot uniek 108 Van trendy tot tijdloos 109 Varsseveld 110
Vertrouwd dichtbij 111 vinyl 112 Waardevolle spullen 113 We zien elkaar 114 Welkom in onze showroom 115
Werelds genieten voor een aangename prijs 116 Werkvoorbereider brandbestrijdingstechniek 117 Werkvoorbereider elektrotechniek 118
Wij hebben daarvoor het les- en speelpakket! 119 Wij produceren messing en koper 120 Wij wensen je een fijne decembermaand 121 Zelfstandig werkend kok 122
Zielsbewustzijn 123 Zonder zout 124 Zorgbeveiliging 125 Zowel voor hem als haar 126 Zwemles is een feestje
ENGINEER / CALCULATOR HVAC
Je ontwerpt en ontwikkelt alle technische componenten ten behoeve van installaties. Je maakt bijbehorende berekeningen, calculaties en duidelijke aanbiedingen in de vorm van offertes.
Asselsestraat 58 7311 EN Apeldoorn tel: 055 5222 757 apeldoorn@clcnederland.com
Bel of mail met Sandra Reumer of Peter-Bart Wernink op 055 577 72 00 of vacature@hamer.net. www.hamer.net/vacatures
DUTCH DESIGN SCANDINAVISCHE KLEDING CADEAU IDEEËN Floris Hovers Kerststal Brink 21, Deventer ingang Roggestraat (t.o. Etty Hillesum Centrum)
53
55
Decemberpuzzel 28 Boeken en
Muziek de betere christelijke boekhandel, ook online! www.clcnederland.com
Het is december en dat betekent dat het weer tijd is voor de Decemberpuzzel van Nieuwsblad Stedendriehoek. Talloze puzzels hebben we al gemaakt en elk jaar weer mogen we talloze inzen dingen van lezers ontvangen. Ook dit jaar vind je weer een gloednieuwe puzzel. Dat betekent niet alleen puz zelplezier, maar natuurlijk ook weer volop kans op het winnen van geweldige prijzen.



























































29 Apeldoorn-Deventer www.herwers.nl Aan de Koninginnelaan 97 in Apeldoorn! Koninginnelaan 79a Apeldoorn 055 - 5221895 Bestel ons assortiment ook op: MELK Verse MELKTA P WILP “Boerderij de Elshof” Zwarte Kolkstraat 22 Wilp Openingstijden melktap dagelijks van 08.00 - 21.00 uur www.melktapwilp.nl Boerderijwinkel en melktap T.G. Gibsonstraat 17 Deventer - 0570 831255 Sinds 1979 Gratis parkeren terwijl wij uw spullen taxeren? www.inkoop-goud-en-zilver.com parkeren uw taxeren? T.G. Gibsonstraat 17 Deventer - 0570 831255 Sinds 1979 Gratis parkeren terwijl wij uw spullen taxeren? www.inkoop-goud-en-zilver.com Puzzelen? Als u uw waardevolle spullen wilt laten taxeren zijn wij de oplossing! WWW. HETINKOOPKANTOOR.NL Je ondersteunt de bedrijfsleider en de projectleider en doet voorbereidende en administratieve werkzaamheden. Ook maak je calculaties en planningen voor meer- en minder werk. Bel of mail met Sandra Reumer of Peter-Bart Wernink op 055 577 72 00 of vacature@hamer.net. www.hamer.net/vacatures WERKVOORBEREIDER ELEKTROTECHNIEK Smeenkhof 31 | Colmschate 0570–658833 | www.starair.nl Dé specialist in zonnepanelen Welkom in de sfeervolle showroom van Mart Kleppe. Tientallen opstellingen met raffinement, omgeven door talrijke aansprekende decoraties. Kom gezellig naar Apeldoorn en maak kennis met alle noviteiten in onze unieke showroom. APELDOORN(NOORD) Vlijtseweg 206 • (055) 526 22 72 WWW.MARTKLEPPE.NL Welkom in de sfeervolle showroom van Mart Kleppe. Tientallen opstellingen met raffinement, omgeven door talrijke aansprekende decoraties. Kom gezellig naar Apeldoorn en maak
met alle noviteiten in onze unieke showroom. APELDOORN(NOORD) Vlijtseweg 206 • (055) 526 22 72 WWW.MARTKLEPPE.NL Kayersdijk 95 Apeldoorn • Tel.: 055-72 00 155 Revalstraat 7 Deventer • Tel.: 0570-59 07 12 Ook toe aan meer leefruimte thuis? Nu tijdelijk 10% korting Op een Greenline of Pro line Veranda Werelds genieten voor een aangename prijs Bij de Expeditie kunt u terecht voor koffie/thee met gebak, lunch of diner van een kaart met invloeden van over de hele wereld. Wij serveren specialiteiten zoals Zwitserse kaasfondue, veel vegetarische en vegan opties, maar ook lekkere vleesgerechten zoals, de saté v/d haas de sappigste burgers en overheerlijke maaltijdsalades. Smedenstraat 9, Deventer 0570-230603 info@Htdeexpeditie.nl Kwaliteit en gastvrijheid staan altijd voorop! vFAS | Familie- en Erfrechtadvocaat Mfn Registermediator | Coach T 085 750 04 74 E info@dijk-ers.nl W dijk-ers.nl UIT ELKAAR MET RESPECT VOOR ELKAAR! >>>>>> STEL ZELF UW KERSTPAKKET SAMEN <<<<< De grootste kerstdozenspecialist van de Stedendriehoek Johan Willem Frisostraat 3 - TWELLO - Tel.: 0571-276347 De grootste groothandel in verpakkingsmaterialen en winkelbenodigheden van de Stedendriehoek >>>>>> STEL ZELF UW KERSTPAKKET SAMEN <<<<< De grootste kerstdozenspecialist van de Stedendriehoek Johan Willem Frisostraat 3 - TWELLO - Tel.: 0571-276347 De grootste groothandel in verpakkingsmaterialen en winkelbenodigheden van de Stedendriehoek Tijdelijk gratis bezorging! • 250 Watt achterwielmotor Bafang • 13 Ah accu in het frame • LCD display, 5 ondersteuningsstanden • Walk Assist functie • Bafang H700 2 versnellingen automaat • 250 Watt voorwielmotor MXUS • 13 Ah accu op bagagedrager • Shimano Nexus 7 versnellingsnaaf • V-brakes voor en rollerbrake achter • Vaste voorvork Villette L’ URBAN € 1399 1499 • Er is meer! Kijk op orpheus.nl Liever theater cadeau. INFOCENTRUM NOORDERHAVEN Lijmerij 23, Zutphen www.noorderhavenzutphen.nl WWW . PRACHT NOORDERHAVEN Laan van Malkenschoten 85 | 7333 NP Apeldoorn (T) 055 - 538 05 00 | broekhuisgroep.nl Is uw Opel toe aan een opfrisbeurt? Rij dan deze maand nog onze werkplaats binnen voor een aircocheck. Decemberpuzzel T 0571-27275 E info@waardigewaard.nl za10:00-01:00 zo 10:00-23:00 di10:00-23:00 wo 10:00-23:00 Dorpsstraat 23 7391 JN Twello T 0571-27275 E info@waardigewaard.nl WAARDIGEWAARD.NL do10:00-23:00 vrij10:00-01:00 za10:00-01:00 zo 10:00-23:00 magesloten di10:00-23:00 wo 10:00-23:00 OPENINGSTIJDEN 0 Kijk voor meer informatie op onze website. 1e en 2e kerstdag gesloten
kennis





























































30 Je voert montagewerkzaamheden uit bij het installeren van tankinstallaties en werkplaatsinrichtingen en verricht pijpfit-, constructie- en grondwerkzaamheden. Je stelt diagnoses en verricht zo nodig reparatiewerkzaamheden. Bel of mail met Sandra Reumer of Peter-Bart Wernink Haan Apeldoorn 0404 Haan Apeldoorn 0404 MarinkaAfscheidshuis de Haan Een unieke, kleinschalige huiselijke omgeving om afscheid te kunnen nemen. Koningstraat 3, Apeldoorn Dag en nacht: 055 576 0404 www.marinkadehaan.nl Voor al uw reparaties, nieuw werk, vermaken van oude sieraden etc. Leonard Springerlaan 166, Deventer www.goudsmid-husselman.nl ontwerpt samen met u uw droomsieraad. Wat velen wellicht niet weten is dat we daarnaast nog veel meer doen! – Stenen- en parelsnoeren op wens. Wij herstellen ook rijgwerk. Een van onze specialiteiten is het maken van een scharnier in een (bestaande) ring die niet meer over de knokkel past. Met deze oplossing is de ring precies op de goede maat en zonder gedraai Oude Zutphenseweg 3A - 7382 SB Klarenbeek - 06-37317269 info@manege-voorst.nl - www.manege-voorst.nl Oude Zutphenseweg 3A - 7382 SB Klarenbeek - 06-37317269 info@manege-voorst.nl - www.manege-voorst.nl Manege Voorst Buitenschoolse opvang Dagbesteding Jeugdzorg Begeleid paardrijden Manege Oude Zutphenseweg 3A - 7382 SB Klarenbeek - 06-37317269 info@manege-voorst.nl - www.manege-voorst.nl Manege Voorst 055-3011352 Rostockstraat 7 • 7418 EL DEVENTER Tel. 0570 623 543 • info@soldicoat.nl www.soldicoat.nl DESIGN GIETVLOER? • Luxe, decoratieve uitstraling • Comfortabel, voelt zacht en flexibel aan • Eenvoudig te reinigen • Te combineren met vloerverwarming • Elastisch en geluiddempend • Ook uw leverancier van kunststof badkamer-, balkon- en garagevloeren! NAADLOOS - DECORATIEF - SLIJTVAST STOP! MET SNURKEN TTL-APPELHOF.NL MUNSTERSTRAAT 26 - DEVENTER - 0570 612261 Wij bespreken uw persoonlijke wensen en geven voorlichting en advies, ook over vergoedingen. Bel ons voor een vrijblijvende en kosteloze eerste afspraak. Keizerstraat 1 7411 HC Deventer 0570 - 745019 Ontbijt - Lunch meer dan 50 soorten hotchocspoons old choc - smoothies - high tea/ high choc biologisch zeer uitgebreid koffie-assortiment Blijf mobiel SCOOTMOBIELEN ROLLATORS & MOBILITEITS HULPMIDDELEN NIEUW & GEBRUIKT Hunneperweg 5 - 7418 EH - Deventer - T. 0570- 611 659 LEUK KADO-IDEE: GOLFLESSEN!! Wij daarvoorhebben hét lesen speelpakket! Je krijgt 6 golflessen, 3 maanden lekker veel golfen, gratis theorieavond, leenset golfclubs, golfballen én veel meer! www.debreuninkhof.nl EUR 175! Golfpark De Breuninkhof, Voorst INFOCENTRUM NOORDERHAVEN Lijmerij 23, Zutphen www.noorderhavenzutphen.nl EEN ONTWIKKELING VAN Heijmans Vastgoed www.heijmans.nl WWW . PRACHT - NOORDERHAVEN . NL Op dinsdag 24 mei jongstleden zijn wij met de verkoop van de appartementen en penthouses gestart. Er is enorm veel belangstelling voor onze appartementen in Pracht, maar ..... er zijn nog Wilt u wonen op misschien wel de mooiste Schrijf u dan in via onze website www.pracht-noorderhaven.nl en kijk welke appartementen nog vrij zijn. Men kent ons mogelijk als Granges, Outokumpu of Aurubis, maar sinds 1 augustus 2022 heten wij KME Netherlands Wij produceren messing en koper halffabricaten die bijvoorbeeld gebruikt worden in de automotive en elektrotechnische industrie Oostzeestraat 1, 7202 CM Zutphen, TEL 0575-594594 Oplaadpunten In het centrum van Deventer 24/7 Open Centrumgarage Op de Keizer 1 7411 TC Deventer 0570 - 616 099 www.centrumgaragedeventer.nl Een warm welkom bij de Centrumgarage! Altijd 18% tot 50% korting op ons gehele assortiment www.keukensale.com De Voorwaarts 45 | 7321 MA Apeldoorn Tel. 055 - 207 07 20 HOOFDSTRAAT 38 APELDOORN - TELEFOON 055-5211778 Open: ma. 13.00-18.00 uur, di. t/m vr. 09.00-18.00 uur, za. 09.00-17.00 uur, do. av. koopavond, zo. altijd gesloten. PRIJZEN GELDEN NA INRUIL FIETS HOOFDSTRAAT 38 - APELDOORN - TELEFOON 055 - 5211778 Open: di. t/m vr. 08.30-17.30 uur, za. 09.00-17.00 uur, do. koopavond tot 20.00 uur. Zondags altijd gesloten. EIGEN VOORRAAD, DUS SNEL GELEVERD! OOK VOOR UW 2E HANDS FIETS EN REPARATIES VAN RIJWIELEN HET JUISTE ADRES! MEER INFO EN AANBIEDINGEN WWW.DIRKBLOK.NL GROTE VOORRAAD NIEUWE & GEBRUIKTE E-BIKES EN FIETSEN MET SERVICE & GARANTIE! DIRK BLOK RIJWIELSPECIALIST RUIM 1300 M2 FIETSPLEZIER! HOOFDSTRAAT 38 - APELDOORN - TELEFOON 055-5211778 Open: ma. 13.00-18.00 uur, di. t/m vr. 09.00-18.00 uur, za. 09.00-17.00 uur, do. av. koopavond, zo. altijd gesloten. PRIJZEN GELDEN NA INRUIL FIETS HOOFDSTRAAT 38 - APELDOORN - TELEFOON 055 - 5211778 Open: di. t/m vr. 08.30-17.30 uur, za. 09.00-17.00 uur, do. koopavond tot 20.00 uur. Zondags altijd gesloten. EIGEN VOORRAAD, DUS SNEL GELEVERD! OOK VOOR UW 2E HANDS FIETS EN REPARATIES VAN RIJWIELEN HET JUISTE ADRES! MEER INFO EN AANBIEDINGEN WWW.DIRKBLOK.NL GROTE VOORRAAD NIEUWE & GEBRUIKTE E-BIKES EN FIETSEN MET SERVICE & GARANTIE! DIRK BLOK RIJWIELSPECIALIST RUIM 1300 M2 FIETSPLEZIER! sfeer in huis... iets moois Melenhorst Antiek Rijksstraatweg 167, Twello | Tel. 0571-273951 | MELENHORST.NL WERKVOORBEREIDER BRANDBESTRIJDINGSTECHNIEK Een echte regelfunctie! Je ondersteunt de projectleiders Brandveiligheid en doet voorbereidende en administratieve werkzaamheden ten behoeve van brandbestrijdingsprojecten. Bel of mail met Sandra Reumer of Peter-Bart Wernink op 055 577 72 00 of vacature@hamer.net. www.hamer.net/vacatures Apeldoorn-Noord, Laan van de Dierenriem 51 Tel. 055 - 3603050 Decemberpuzzel
















































31 MONTEUR BRANDBESTRIJDINGSTECHNIEK Je bent verantwoordelijk voor het in bedrijf stellen van nieu we installaties en service & onderhoudswerkzaamheden aan de brandbestrijdingssystemen. Het lokaliseren, analyseren en oplossen van storingen behoort tot je dagelijks werk. Bel of mail met Sandra Reumer of Peter-Bart Wernink op 055 577 72 00 of vacature@hamer.net. www.hamer.net/vacatures www.oldevakkerieje.nl Nieuwe Classic Oldtimers binnen! Walstraat 55, Grolstraat 1&5 Deventer 0570 - 616 179 06 - 39 216 012 Zwolseweg 221 • Apeldoorn 055-2002037 bodywearsuperstore.nl Gratis parkeren voor de deur! Bodywear Superstore is de grootste lingeriewinkel van Nederland. U vindt bij ons in de winkel een zeer uitgebreide collectie aan lingerie, badmode en nachtmode! Zowel voor hem als haar. Smeenkhof 31 | Colmschate | 0570–658833 | www.starair.nl Koelen Verwarmen Ventileren Drogen Dé Airconditioning specialist Paulus Potterstraat 6 Zutphen tel. 085 - 773 37 52 Dikkertje Dap www.kinderopvangdikkertjedap.nl Biedt professionele flexibele kinderopvang. Opslagruimte nodig in Zutphen? Reserveer direct via onze website Self Storage of Car Storage nodig in Zutphen? Reserveer eenvoudig online www.sallandstorage.nl | (0575) 796 070 De Stoven 1, 7206 AZ Zutphen 1,49m 2,23m 2,28m 2,86m 2,23m 2,28m 7m2 / 16m3 79,- per 4 weken 3,5m2 / 8m3 39,- per 4 weken Self Storage of Car Storage nodig in Zutphen? Reserveer eenvoudig online www.sallandstorage.nl | (0575) 796 070 De Stoven 1, 7206 AZ Zutphen 1,49m 2,23m 2,28m 2,86m 2,23m 2,28m 7m2 / 16m3 79,- per 4 weken 3,5m2 / 8m3 39,- per 4 weken www.sallandstorage.nl De Stoven 1, 7206 AZ Zutphen info@sallandstorage.nl | (0570) 629 231 Self Storage of Car Storage nodig in Zutphen? Reserveer eenvoudig online www.sallandstorage.nl | (0575) 796 070 1,49m 2,23m 2,28m 2,86m 2,23m 2,28m 7m2 / 16m3 79,- per 4 weken 3,5m2 / 8m3 39,- per 4 weken Self Storage of Car Storage nodig in Zutphen? Reserveer eenvoudig online www.sallandstorage.nl | (0575) 796 070 De Stoven 1, 7206 AZ Zutphen 1,49m 2,23m 2,28m 2,86m 2,23m 2,28m 7m2 / 16m3 79,- per 4 weken 3,5m2 / 8m3 39,- per 4 weken Opslagruimte nodig? Reserveer eenvoudig online. KEI COACHING EN TRAINING www.keicoachingentraining.nl | info@keicoachingentraining.nl | Tel.: 06-28498645 www.lavorista.nl www.carlosinhuis.nl Hofstraat 13-15, 7411 PD Deventer t 0570 54 64 64, info@carlosinhuis.nl Natuurkisten Draagkisten | Draagbaren Draagplanken Waden en Wikkeldoeken | Urnen en As-tassen | Hemden en Uitvaarttextiel Jute rouwlinten | Koestermandjes en Kistjes Bezoek showroom op afspraak: Sinderenseweg 1, 7051 HD Varsseveld. NATUURKISTEN ACHTERHOEK WWW.NATUURKIST.NU | INFO@NATUURKIST.NU HOGEWEG 7A, 7055 AJ HEELWEG | TEL. 06-81283387 OF 06-12448345 Altijd 18% tot 50% korting op ons gehele assortiment www.sanisale.com De Voorwaarts 45 (volg Omnisport) | 7321 MA Apeldoorn Tel. 055 - 207 07 20 Wij wensen je een fijne decembermaand! Fit Fellows is het alternatief voor de normale sportschool Fit en slank in 2x 30 min per week! WINKELCENTRUM ANKLAAR APELDOORN• WWW.FITFELLOWSCLUB.NL • T 055 - 3030802 • FACEBOOK.COM/FITFELLOWS M P *Actie geldig t/m 31 December 2022 Schrijf je NU in en sport tot het einde van het jaar GRATIS - AFVALLEN - MINDER RUGKLACHTEN - BLIJF JONG EN FIT Dorpsstraat 13a 7431 CG Diepenveen Dorpsstraat 17 | Twello | 0571 746020 | info@bw-s.org | www.bw-s.org Decemberpuzzel
PROJECTLEIDER ELEKTROTECHNIEK







Je wordt verantwoordelijk voor service & onderhoud van het laadnetwerk bij onze klanten. Je coördineert en controleert de werkzaamheden van je team op kantoor en op locatie bij de klant.



Bel of mail met Sandra Reumer of Peter-Bart Wernink op 055 577 72 00 of vacature@hamer.net. www.hamer.net/vacatures
























































“Een goed afscheid is een geschenk voor het leven.”
“Een goed afscheid is een geschenk voor het leven.”
“Een goed afscheid is een geschenk voor het leven.”

















een geschenk voor het leven.”
We gaan met elkaar op zoek naar passende mogelijkheden voor een waardig en persoonlijk afscheid.
We gaan met elkaar op zoek naar passende mogelijkheden voor een waardig en persoonlijk afscheid.
We gaan met elkaar op zoek naar passende mogelijkheden voor een waardig en persoonlijk afscheid.
We gaan met elkaar op zoek naar passende mogelijkheden voor een waardig en persoonlijk afscheid.


Neem gerust contact op! Ik sta dag en nacht voor u klaar.
Neem gerust contact op! Ik sta dag en nacht voor u klaar.
Neem gerust contact op! Ik sta dag en nacht voor u klaar.
Neem gerust contact op! Ik sta dag en nacht voor u klaar.












































































































Maroesjcha Branderhorst
Maroesjcha Branderhorst
Maroesjcha Branderhorst







t: 06-411 700 06 e: m@branderhorst-uitvaartzorg.nl w: www.branderhorst-uitvaartzorg.nl
t: 06-411 700 06 e: m@branderhorst-uitvaartzorg.nl w: www.branderhorst-uitvaartzorg.nl
ByMonika Praktijk voor Energie Spiritueel & Psychosociaal Coaching, Magnetiseur, Aromatherapie, Bach Bloesem Frequenties, Holistisch & Wellness Masseur Meer informatie kijk op www.monikabruntink.nl 0613 277 181 Wilp Gem Voorst Ervaar de diepe ontspanning & kom thuis LEEG JE HOOFD, KOM IN JE VEL HEERLIJK ONTSPANNEN ZWEVEND EN DROMERIG, aromatische omgeving ENERGIE & FREQUENTIES ONTSPANNEN: Boek jouw "Me-Time met 15% korting voor 31 dec en geniet in januari en/of februari van een : "Warme-EnergetischeWellness-massage" ByMonika SINDS 1-1-2011 O N T S P A N N E N Boek jouw “Me-Time met 15% korting voor 31 dec en geniet in januari en/of februari van een : “Warme-Energetische-Wellness-massage” HEERLIJK ONTSPANNEN ZWEVEND EN DROMERIG, HOOFD LEGEN & IN VERBINDING ZIJN SINDS 1-1-2011 Praktijk voor Energie Spiritueel & Psychosociaal Coaching, Magnetiseur, Aromatherapie, Bach Bloesem Frequenties, Holistisch & Wellness Masseur Meer informatie kijk op www.monikabruntink.nl 0613 277 181 Wilp Gem Voorst ByMonika Praktijk voor Energie Spiritueel & Psychosociaal Coaching, Magnetiseur, Aromatherapie, Bach Bloesem Frequenties, Holistisch & Wellness Masseur Meer informatie kijk op www.monikabruntink.nl 0613 277 181 Wilp Gem Voorst Ervaar de diepe ontspanning & kom thuis LEEG JE HOOFD, KOM IN JE VEL HEERLIJK ONTSPANNEN ZWEVEND EN DROMERIG, HOOFD LEGEN & IN VERBINDING ZIJN Genieten in een aromatische omgeving ENERGIE & FREQUENTIES ONTSPANNEN: Boek jouw "Me-Time met 15% korting voor 31 dec en geniet in januari en/of februari van een : "Warme-EnergetischeWellness-massage" ByMonika SINDS 1-1-2011 Woonboulevard “De Mars” - Jutlandsestraat 3, Zutphen - Tel: 0575-517999 www.kachelswk.nl - www.duurzamecvsystemen.nl In uw woning, genieten van de warmte en het gemak van een gashaard? Kies dan voor propaan!! Voor meer informatie bezoek onze showroom. Gesloten van zaterdag 24 december t/m 4 januari InstalCenter van Tongeren Loodgieters-eninstallatiebedr ijf van Tongeren Komnaardeshowroomenkr ndespecialist! Loodgieters-enins tallatiebedr ijf van Tongeren Asselsestraat 249-251, 7312 CTApeldoorn, Tel.:055355 3782,www.ins talcenter.nl Uwmeterstandals lotnummer... Ganulangsbij uwInstalCenter ofkijkop ketelbingo.nl *VraagindewinkelnaardeMAT - FLAME - SOFTONE Loodgieters- en installatiebedrijf van Tongeren Asselsestraat 249-251, 7312 CT Apeldoorn, Tel.: 055 355 3782, www.vantongerenapeldoorn.nl Kom naar de winkel en krijg gratis advies van de specialist! Asselsestraat 249-251, Apeldoorn, Tel.: 055 3553782 www.instalcenter.nl, www.vantongerenapeldoorn.nl LAMPEN NODIG? Simson tapijt Everlaan 29 - 7315 WZ Apeldoorn (‘t Loo) Telefoon: 055 5211350 - www.simsontapijt.nl Tapijt Vinyl Laminaat Gordijnen Zonwering ZOMERPUZZEL VAN HAVERKAMP AUTO’S mee en win mooie prijzen bij Nieuwsblad Stedendriehoek. Winnaars krijgen persoonlijk bericht. Stuur je oplossing naar: puzzel@stedendriehoek.nl o.v.v. zomerpuzzel 2021 + Bedrijfsnaam puzzel Haverkamp WIJHPOOKNIECIVRES VOORRAADFAHCSNAA ODESKUNDIGINRUIL UITWELLOCCASIONS SEADENUPMAKREVAH IJHNPMOSTAALPKREW RRKBKIAIRCOCHECK PESAELSPECIALIST FDTVAKANTIECHECK ALASCHADEHERSTEL HETEITARAPERSALG CHIEXPORTSERVICE STORINGSDIAGNOSE NENNOITATSWUOBNI ALLAANOITANRETNI AONDERHOUDSBEURT AANSCHAF AANSCHAFPRIJS AIRCOCHECK APK DESKUNDIG EXPORTSERVICE GLASREPARATIE HAVERKAMP HELDERHEID INBOUWSTATION INKOOP INRUIL INTERNATIONAAL LEASE OCCASIONS ONDERHOUDSBEURT SCHADEHERSTEL SERVICE SPECIALIST STORINGSDIAGNOSE TANKSTATION TWELLO VAKANTIECHECK VOORRAAD WERKPLAATS 350 AUTO’S OP VOORRAAD WWW.HAVERKAMP.NL Woudweg 7, Teuge Weteringstraat 4, Twello tel. 055-3231210 e-mail: info@haverkamp.nl ma-vr 08.30 - 17.30 uur za 08.30 - 15.00 uur; zo gesloten Walstraat 19, Deventer T. 0570 618855, /DeKruidnagel www.dekruidnagel.nl Sokken van Merino-wol! Wij plaatsen en leveren aan particulieren en bedrijven GLAZEN DEUREN EN PUIEN GEEN RUIT IS TE KLEIN OF TE GROOT Molenstraat 145, 7321 BD Apeldoorn, T. 055 - 366 66 66 showroom geopend van ma. t/m vrij. va 08.00 tot 17.00 info@la-paloma.com • www.la-paloma.com Specialist in autoherstel, ruitherstel en caravan/camperherstel Vakkundige en snelle reparatie door schadespecialisten Dag en nacht bereikbaar Gratis haal- en brengservice Gratis vervangende auto Gratis verhalen van uw WA autoschade Vier jaar schriftelijke FOCWA // BOVAG garantie Meerdere merkerkenningen Wij repareren voor elke verzekeringsmaatschappij Gecertificeerd Duurzaam Herstel SURINAMEWEG 27 / 7333 PC APELDOORN / 055-5342522 ZWEEDSESTRAAT 17 / 7418 BG DEVENTER / 0570-635707 RIEZEBOSWEG 6 / 8171 MG VAASSEN / 0578-571227 HTH AUTOSCHADE PLUSPUNTEN OP EEN RIJ: Molenstraat 28 | 0571 29 85 19 | lilyen.nl Bij ons altijd meer dan 75 soorten plukbloemen. • Plukboeketten • Afscheidsbloemen • Bruidsbloemen • Abonnementen • Cadeau(bon) Walstraat 45, Deventer 06-42270957 Proefwinkel To-go-loket Koffie/theewinkel www.roemarkoffiebranderij.nl Venus bloem en lijn; blauw #82CBD2 Fonts; bamboe goud #A37A1F A37A1D Type Font; Filson soft Light www.dokterbloemleefstijlkliniek.nl Lidmaatschappen Beweging Ontspanning Eten en drinken Motieven Wist je dat BLOEM® staat voor alle aspecten die belangrijk zijn voor je gezondheid? Maroesjcha Branderhorst t: 06-411 700 06 e: m@branderhorst-uitvaartzorg.nl w: www.branderhorst-uitvaartzorg.nl WAAR U OOK VERZEKERD BENT, IK STA U GRAAG BIJ. “Een goed afscheid is
U OOK
t: 06-411 700 06 e: m@branderhorst-uitvaartzorg.nl w: www.branderhorst-uitvaartzorg.nl WAAR
VERZEKERD BENT,
IK STA U GRAAG BIJ.
WAAR U OOK VERZEKERD BENT, IK STA U GRAAG BIJ.
WAAR U OOK VERZEKERD BENT, IK STA U GRAAG BIJ.
• 250 Watt achterwielmotor Bafang • 13 Ah accu in het frame • LCD display, 5 ondersteuningsstanden • Walk Assist functie • Bafang H700 2 versnellingen automaat Villette L’ AMANT Automatic 1499 vertrouwd dichtbij thuis- en woonzorg Bel 0900 86 62 of kijk op www.carinova.nl Oerdijk 19, 7433 AE Schalkhaar Asselsestraat 61b, 7311 ED Apeldoorn Decemberpuzzel 32
De grootste van Nederland
De grootste van Nederland
















OPENINGSTIJDEN maandag: 13.00 - 18.00 uur dinsdag t/m vrijdag: 09.00 - 18.00 uur (geen koopavond) zaterdag: 10.00 - 16.00 uur • Volg ons op facebook Kijk ook eens op biljartwinkel.nl
OPENINGSTIJDEN maandag: 13.00 - 18.00 uur dinsdag t/m vrijdag: 09.00 - 18.00 uur (geen koopavond) zaterdag: 10.00 - 16.00 uur • Volg ons op facebook Kijk










































Laan van orden 199, TeL. 055 - 3560804 www.devischmarkT.nL












33 • Horecabeveiliging • Evenementenbeveiliging • Objectbeveiliging • Zorgbeveiliging • Winkelsurveillance t: 06 - 42 78 23 13 e: info@hanze-security.nl w: www.hanze-security.nl Erkend door het ministerie van justitie: ND3481 MASTERPIECES.NL NIEUWSTRAAT 53 7411 LH DEVENTER Voor kerstcadeaus ga je naar Masterpieces Mooi voor elkaar www.electroworldhamer.nl Winkelcentrum ´Kayershof´ Mgr. Nolensstraat 61 Apeldoorn 055 - 5332166 info@radiotvhamer.nl DE GULDEN KNOOP Lederwaren Spijkerboorsteeg 8, Deventer 0570 - 649774, www.deguldenknoop.nl Kledingreparatie- en Verstelatelier Verkoop van: Riemen - Handschoenen Tassen - Portemonnees etc. Broekland Van Dongenstraat 38 Tel: 0570 - 531035 www.uwtuinenpark.nl Lemele Lemelerweg 25c Tel: 0572 - 331341 www.bmb-bruggeman.nl Gratis advies op maat bij u op locatie Broekland Van Dongenstraat 38 Tel: 0570 - 531035 www.uwtuinenpark.nl Lemele Lemelerweg 25c Tel: 0572 - 331341 www.bmb-bruggeman.nl Uw eigen Robomow Robotmaaier Al vanaf € 499,Gratis advies op maat Broekland Van Dongenstraat 38 Tel: 0570 - 531035 www.uwtuinenpark.nl Lemele Lemelerweg 25c Tel: 0572 - 331341 www.bmb-bruggeman.nl Uw eigen Robotmaaier Al vanaf € 799,STIJLVOLLE GEDENKTEKENS Modeltuin aan de Koningslijn met meer dan 300 gedenkstenen KONINGSLIJN 3, APELDOORN TEL. 055 - 576 05 85 INFO@HOOGENBERG WEGERIF NL WWW HOOGENBERG WEGERIF NL Mus Verpakkingen BV Herfordstraat 9, 7418 EX Deventer, Industrieterrein Kloosterlanden 2 tel.: 0570-629229 | www.musverpakkingen.nl fax: 0570-636453 | info@musverpakkingen.nl STORINGSCOORDINATOR Je neemt meldingen, storingen, schades e.d. aan van onze klanten van voornamelijk onbemande tankstations en registreert deze in ons systeem. Vervolgens bepaal je de actie en bewaak je de afhandeling hiervan. Bel of mail met Sandra Reumer of Peter-Bart Wernink op 055 577 72 00 of vacature@hamer.net. www.hamer.net/vacatures Maduralaan 2, 7314 CH Apeldoorn Telefoon: 088 812 2333 Email: Ladylineapeldoorn@ladyline.nl Stralend, fit en vitaal de kerst in Stok achter de deur nodig? A P E L D O O R N Eendrachtstraat 103 - Apeldoorn tel. 055 360 45 41 wwww.meestelijkgeschikt.nl Praktijk en opleiding voor Zielsgerichte Regressie en Reïncarnatie Therapie 06-12694272 www.samskara.nl Hermine Merlijn Samskara Cursus “Zielsbewustzijn” Tweede Kerstdag geopend. 1e Kerstdag en Nieuwjaarsdag GESLOTEN ‘t Pannekoekhuis DEVENTERSTRAAT 172 tel. 055 - 366 71 21 WWW.PANNENKOEKHUIS-APELDOORN.NL MA./Di N. VANA f 16.00 uuR wo E. T/M zo N. VANA f 12.00 uuR “ Administratie goed voor elkaar? Voor administratie en adviezen ga je naar AD2DI. Spittaalstraat 54, 7201 EE Zutphen www.ad2di.nl Op zoek naar een Administratiekantoor?
ook eens op biljartwinkel.nl
Juwelier G. L. de Bruijn Kom kijken en vergelijken Betrouwbare kwaliteits horloges en klokken (zoals hang- en tafelklokken) Tevens voor reparatie van al uw sieraden Asselsestraat 129 - Apeldoorn - Tel. 055-5215007 Een liefdevol afscheid kan helpen het verlies van uw huisdier te verwerken. De medewerkers van Huisdierencrematorium De Engelenburg hebben, net als u, een groot hart voor dieren. Zij zullen er alles aan doen om u te adviseren om de crematie als een waardig afscheid te laten verlopen. TWELLO Engelenburgstraat 42, 7391 AM Twello T 0571-700518 l www.hcde.nl Engelenburgstraat 42, 7391 AM Twello T 0571-700518 l www.hcde.nl Voor een waardig afscheid van huisdieren. Huisdierencrematorium De Engelenburg SERVICEMONTEUR ELEKTROTECHNIEK Je doet zelfstandig servicewerkzaamheden binnen het vakgebied Elektrotechniek. Je lokaliseert, analyseert en lost storingen op. Tevens draai je mee in de storingsdiensten. Bel of mail met Sandra Reumer of Peter-Bart Wernink op 055 577 72 00 of vacature@hamer.net. www.hamer.net/vacatures RouwKado2go www.rouwkado2go.nl Rouwkado2go maakt passende en persoonlijke aandenkens om mee te geven aan betrokkenen voor een bijzonder afscheid Paulien 06-30003544 RouwKado2go www.rouwkado2go.nl Rouwkado2go maakt passende en persoonlijke aandenkens om mee te geven aan betrokkenen voor een bijzonder afscheid Paulien 06-30003544 Rouwkado2go telefoon: Paulien 06-30003544 Bas: 06-29047274 Geeft workshops over Rouw in Deventer 15 December: Herinneringsarmband maken (praktisch aan de slag met je Rouw) 12 Januari : Over Rouw (theorie en muziek) Meer info: www.Blackeffect.nl of www.BasBuitenCoach.nl HET LEUKSTE MUSEUM VOOR JONG EN OUD! WWW.AMBACHTENMUSEUM.NL Rijksweg 87 | Terschuur (Veluwe) | 0342 – 46 20 60 Ga mee op ontdekkingsreis! SCAN ME Decemberpuzzel
Kom binnen







afspraak om de collecties te bekijken.







Of bekijk de collecties online, zodat u altijd op de hoogte bent van de laatste trends.

























































































uitgebreide






















34 Bloemenmagazijn “Margriet” Schubertlaan 20, 7333 CV Apeldoorn Tel. 055 - 5332655 www.flowerserviceapeldoorn.com info: margrietbloemen@vbw-groenplein.nl 6 DAGEN PER WEEK OPEN V.A. 8.00 UUR Wij maken het verschil in kwaliteit, kwantiteit, bediening en service AL 40 JAAR UW BLOEMENSPECIAALZAAK! SPOORSTRAAT 1, 7437 TS BATHMEN TEL.: 06 19 471 656 WWW.WILCO-OPTIEK.NL
Baruch Eyewear, Oxibis, Imago Ultralight, Dutz, Sir John, Sara John en 1921 is er een collectie monturen in huis die voor iedereen wat te bieden heeft.
Een
collectie Van trendy tot tijdloos, van subtiel en stijlvol, tot stoer en robuust: er is in elk (prijs)segment een mooie, passende bril te vinden. Met merken als Francois Pinton, Exalto, Red kinderbrillen, Albert I’m Stein,
of maak vrijblijvend een
Fam. Hulscher, Grotenhuisweg 55, Wilp (Posterenk), 06-13029363 www.famhulscher.nl KERSTBOMEN De mooiste bomen vers van het land Diverse soorten en maten A-keus: Fraseri Nordman-Blauwspar + gratis voedingstablet Nieuw: de Turkse Nordman Dagelijks vanaf 08.30 tot 18.30 uur (JUNIOR) INTERCEDENT Je werft en selecteert potentiële uitzendkrachten en organiseert sollicitatiegesprekken. Tevens trek je alle re gisters opent om Jans Uitzendbureau onder de aandacht te brengen bij nieuwe uitzendkrachten en werkgevers. Bel of mail met Sandra Reumer of Peter-Bart Wernink op 055 577 72 00 of vacature@hamer.net. www.hamer.net/vacatures Zozijn biedt liefdevolle en vakkundige ondersteuning aan: • volwassenen met een verstandelijke beperking • kinderen en jongeren met een ontwikkelingsprobleem • volwassenen, kinderen en jongeren met niet-aangeboren hersenletsel We zien elkaar www.zozijn.nl Wie ben jij? Wat houdt je bezig? Bij Zozijn zijn we geïnteresseerd in jou! STRAATWERKEN Tuinontwerp Tuinaanleg Tuinonderhoud Straatwerk Holterweg95a,ColmschateT:0570-652714 E:info@decolm.nlI:www.decolm.nl Hoveniersbedrijf CreatiefDeskundigBetrouwbaar De Colm, ook voor al uw straatwerk Transportweg 8 | 7442 CT Nijverdal 0548-541919 | WWW.GREENLINEKOZIJNEN.NL Kijkvoorallemogelijkhedenopwww.greenlinekozijnen.nl Henry van den Berg Uitvaartzorg Henry van den Berg Uitvaartzorg Heeft u uw uitvaartwensen al vastgelegd? Vraag vrijblijvend het gratis uitvaartwensen boekje aan. 055-2032214 www.hvdberguitvaartzorg.nl • Rust en aandacht • Jarenlange ervaring • Ongeacht waar u verzekerd bent • MXUS achterwielmotor 250 W, 24 V • 7.8 Ah, 24V, 187 Wh accu, uitneembaar • 20 inch dubbelwandige velgen • Kettingscherm • V-brakes voor en achter Villette le Balade Orus € 699 € 899 STOFFENMARKT XXL LOCHEMSEWEG 3 EPSE javro.nl Demooiste stoffenzaakvan Nederland! GRATIS PARKEREN Tullekensmolenweg 37 | 7361 EN Beekbergen | 055-5063131 info@tuincentrumtullekensmolen.nl | www.tuincentrumtullekensmolen.nl KERSTBOMEN TE KOOP Bij aankoop van een kerstboom nu een gratis mandje! P Voor jong & oud Wilt u meer informatie over de diensten van RSC Wilp? MAIL ONS GERUST! Van Twickelostraat 13, 7411 SC Deventer telefoon: 0570-547120 mobiel: 06-46290269 www.advocatenkantoorschinkel.nl e-mail: schinkel@ advocatenkantoorschinkel.nl Mr. Sigrid Schinkel SPECIALIST IN ARBEIDSRECHT Drogisterij BRENDA Reformhuis Asselsestraat 132, 055-5212056 www.drogisterijbrenda.nl - !/DrogisterijBrenda Op alle producten van AOV - Orthica - Solgar 10% korting Geldig t/m 31 december 2022 Tegen inlevering van deze advertentie Decemberpuzzel














































































iedere OPEN ZONDAG Meubels & Kleding WWW.JOHNBARDALE.COM GRATIS BEZORGING COMFORTABEL ZITCOMFORT Hoofdstraat 47e in Gorssel Spittaalstraat 6-8 in Zutphen MET EIGEN BEZORGERS ALLROUND MONTEUR HYDRAULIEK Je verricht montage- en reparatiewerkzaamheden en periodieke keuringen aan autolaadkranen, hoogwerkers, heftrucks en grondverzetmachines. Ook het aansturen van één of meerdere (hulp)monteurs is voor jou geen probleem. Bel of mail met Sandra Reumer of Peter-Bart Wernink op 055 577 72 00 of vacature@hamer.net. www.hamer.net/vacatures ÚW ADRES VOOR VERLOVINGSEN TROUWRINGEN. Hoofdstaat 65, Apeldoorn T. 055-5786411 - E. info.juwelierroyals.nl www.hafkampnatuursteen.nl De Meente 7 - Olst - Tel.: 0570-562 648 ch WIJ U SEREN Brodazz Beach COCKTAILS PIZZA'S DINER MUZIEK HOFSTEDE DE MIDDELBURG ZORGEN WIJ VOOR EEN DAG OM NOOIT TE info@brodazzbeach.nl www.brodazzbeach.nl OOK OP DEZE LOCATIE HELPEN WIJ U GRAAG VERDER MET HET ORGANISEREN VAN EEN FEEST/PARTIJ! Brodazz Beach COCKTAILS PIZZA'S DINER MUZIEK info@brodazzbeach.nl www.brodazzbeach.nl OOK OP DEZE LOCATIE HELPEN WIJ U GRAAG VERDER MET HET ORGANISEREN VAN E EN FEEST/PARTIJ! Brodazz Beach COCKTAILS PIZZA'S DINER MUZIEK HOFSTEDE DE MIDDELBURG BEDRIJFSFEESTEN BRUILOFTEN PARTIJEN info@hofstedemiddelburg.nl www.hofstededemiddelburg.nl NIEUWSGIERIG NAAR ONZE VELE MOGELIJKHEDEN? DOOR ONZE RUIME ERVARING OP HET GEBIED VAN FEESTEN EN PARTIJEN, ZORGEN WIJ VOOR EEN DAG OM NOOIT TE VERGETEN, info@brodazzbeach.nl www.brodazzbeach.nl OOK OP DEZE LOCATIE HELPEN WIJ U GRAAG VERDER MET HET ORGANISEREN VAN EEN FEEST/PARTIJ! G Brodazz Beach COCKTAILS PIZZA'S DINER MUZIEK HOFSTEDE DE MIDDELBURG BEDRIJFSFEESTEN BRUILOFTEN PARTIJEN info@hofstedemiddelburg.nl www.hofstededemiddelburg.nl NIEUWSGIERIG NAAR ONZE VELE MOGELIJKHEDEN? DOOR ONZE RUIME ERVARING OP HET GEBIED VAN FEESTEN EN PARTIJEN, ZORGEN WIJ VOOR EEN DAG OM NOOIT TE VERGETEN, info@brodazzbeach.nl www.brodazzbeach.nl OOK OP DEZE LOCATIE HELPEN WIJ U GRAAG VERDER MET HET ORGANISEREN VAN E EN FEEST/PARTIJ! werkenbij.hollandertechniek.nl WERKTUIGBOUWKUNDE BEVEILIGINGSTECHNIEK ELEKTROTECHNNIEK INDUSTRIËLE AUTOMATISERING RETAILTECHNIEK APELDOORN | ALMERE | AMERSFOORT | ALMELO Banden van een Sparta MC 50 verpleegstersbrommer, 1960. Scheltens Abbenes, 2022, pigment print op dibond coda-apeldoorn.nl/scheltensabbenes THE SHOWCASE unboxing the CODA collection Scheltens & Abbenes G.SCHRIJVER B.V. GROOTHANDEL IN OUD PAPIER, IJZER METALEN & PLASTIC FOLIE Vlijtseweg 212 7317 AN Apeldoorn Tel: 055-5216363 G.SCHRIJVER GROOTHANDEL IN Vlijtseweg 212 AN Apeldoorn 055-5216363 055-5211489 G.SCHRIJVER B.V. GROOTHANDEL IN OUD PAPIER, IJZER METALEN & PLASTIC FOLIE Vlijtseweg 212 7317 AN Apeldoorn Tel: 055-5216363 Al Wij betalen u een eerlijke prijs! Openingstijden: van maandag t/m vrijdag 7.30 uur tot 17.00 uur, zaterdag van 8.00 uur tot 12.00 uur G.SCHRIJVER GROOTHANDEL IN Vlijtseweg 212 AN Apeldoorn 055-5216363 055-5211489 Al 62 Wij wensen iedereen fijne feestdagen en een heel gezond en gelukkig 2023 Zaterdag 24 december, maandag 26 december en zaterdag 31 december gesloten. Vanaf maandag 2 januari 2023 zijn we weer normaal geopend. IK STA U BIJ, ONGEACHT WAAR U VERZEKERD BENT Dag en nacht bereikbaar Peter de Lange Uitvaartverzorger - 06 17 37 09 95 ‘Vertrouwd en betrokken’ info@peterdelangeuitvaartzorg.nl - www.peterdelangeuitvaartzorg.nl Doorbraak tegen kalkaanslag! Zonder zout Zonder stroom Zonder afvoer www.h2opro.nl Van Brandenburgstraat 2 8061 CN Hasselt (ov) tel.: +31 85 130 39 91 €675,-





























* Suzuki Financial Services leasetarief per maand o.b.v. Suzuki Private Lease, 60 mnd, 10.000 km/jaar, wegenbelasting in provincie Gelderland, BTW, en excl. brandstof • Tarieven kunnen afwijken bij gekozen uitvoering, wijziging van opties, looptijd, kilometrage en gewicht • Meerkilometerprijs varieert tussen € 0,03 en € 0,19 per km, exacte prijs staat vermeld op de offerte • Toetsing en registratie BKR • Onder voorbehoud van acceptatie • Wijzigingen en typefouten voorbehouden. Kom snel langs bij Pijnappel Automobielen B.V. Kanaal Noord 200 · 7322 AD Apeldoorn · Tel 055-3664400 · www.pijnappel.nl SUZUKI VITARA SMART HYBRID €395,PRIVATE LEASE V.A. P/M €26.999,V.A. Gemiddeld brandstofverbruik volgens de WLTP testmethodiek Euro-6-norm EC 2018/1832AP: 5,3 – 5,8 l/100 km; 18,9 – 17,2 km/l; CO2-uitstoot: 121 – 131 g/km. serious about fun Spontaan naar Antwerpen voor de lunch. De multifunctionele alleskunner. Jouw nieuwe Vitara heeft een modern en herkenbaar SUV-design, mooi! Als zuinige en super betrouwbare allroader is de Vitara uitgeroepen door de ANWB als meest waardevaste auto, voortreffelijk. En wat ‘m nog aantrekkelijker maakt is dat hij nu ook verkrijgbaar is met een nieuwe ef ciënte Full Hybrid aandrijving. De Vitara schittert van de geavanceerde technieken, het Suzuki Multimedia System en het Suzuki Safety System Pro omdat veiligheid geen grenzen kent. Over grenzen gesproken … met 1500 kg trekgewicht kan je ook spontaan door naar de La Rochelle. Een lunch aan zee … waarom niet? Kom ‘m bewonderen in de showroom of plan gelijk een heerlijke proefrit met de Vitara. 36 GAAN WIJ VERHUIZEN JANUARI 2023 HUIDIGE LOCATIE SLECHTS 2 STRATEN VERDEROP KANAAL NOORD ONS NIEUWE ADRES: LAAN VAN DE DIERENRIEM 38 IN APELDOORN WWW.PIJNAPPEL.NL WATERSCHAP GAAN WIJ VERHUIZEN NIEUWE LOCATIE HUIDIGE LOCATIE SLECHTS 2 STRATEN VERDEROP KANAAL NOORD ONS NIEUWE ADRES: LAAN VAN DE DIERENRIEM 38 IN APELDOORN WWW.PIJNAPPEL.NL WATERSCHAP GAAN WIJ VERHUIZEN JANUARI 2023 NIEUWE LOCATIE HUIDIGE LOCATIE SLECHTS 2 STRATEN VERDEROP KANAAL NOORD ONS NIEUWE ADRES: LAAN VAN DE DIERENRIEM 38 IN APELDOORN WWW.PIJNAPPEL.NL WATERSCHAP JANUARI 2023 GAAN WIJ VERHUIZEN ONS NIEUWE ADRES: LAAN VAN DE DIERENRIEM 38 IN APELDOORN